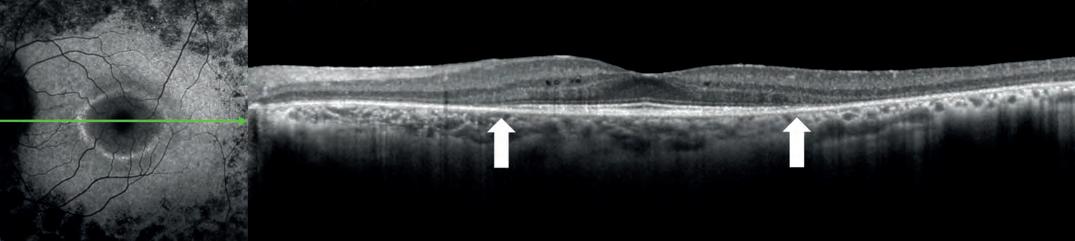

Adam Sampson
Adam Sampson
The cat and mouse game of being heard politically as a general election looms has begun, writes Adam Sampson

At times like this, when we are nearing, not merely an election, but one that – if the polls are right – will see a seismic shift in the political landscape, things get very interesting. On the plus side, access suddenly becomes much easier as ministers, focused on the necessity of getting re-elected, seek routes to engage with the very organisations they have spent the previous few years keeping at arm’s length. On the minus side, meetings become less useful as election day approaches, with little chance of action being taken. We have seen this pattern play out over the past few months. For my first year at the AOP, there was little contact with any ministerial team. The following year, we got in front of ministers on three occasions. In the past six months, I or other AOP team members have had half a dozen ministerial encounters – and not just junior ministers, but time with both the Health Secretary and the Chancellor. While it is nice to be able to report that you have met such and such, that is not the metric that matters. It is action that matters. In the final months of an administration, ministerial power ebbs quickly. While they can, they will wish to be announcing new, popular initiatives, but unless those promises can be delivered quickly, they are more likely to be soundbites than realities. For example, the extended services eye care pathway, requested by the (then) minister last year, has been pulled back into a further NHSE endorsement process that will delay its formal adoption.

16,875 STEPS
It is not just access that changes. It is also what you talk about. The short-term, tactical asks go back into your pocket. Replacing them are the longer-term ideas, the sort of changes that will take years to implement and which will help to shape the overall approach of the new administration. IT integration and data sharing, modernised regulation, moving resources from a bloated secondary care system into a joined-up primary care one; a review of the clinical commissioning model for eye care services in England – these are the sorts of conversations we need to be having. Let’s hope that the people we are talking to are the ones who will be in place to implement them over the next five years…
Adam Sampson, AOP chief executive


In the final instalment of OT’s special report series investigating independent prescribing, we look at how changes to this further qualification are









OT features a range of expert contributors who share their optometry expertise and insight. Here are some of those who helped us put this edition together

Fighting for a better optometry world
Earlier this year the AOP hosted a roundtable event with practitioners in partnership with Marsha de Cordova MP. OTreports on the value and potential of High Street optometry
What would your one eye care ask for the next Government be?

“The system for educating ECPs is inefficient and based on historical professional boundaries –please review to make it fit for future challenges.”
Professor David Thomson, CEO of Thomson Software Behind the brand, page 81


“Remove advance notification requirements for mobile sight tests in England. I believe they serve no benefit to the patient. Rather, they delay access to care, create barriers, and inhibit possible timely intervention for patients.”
Kirsty McLardy, Specsavers domiciliary optometry director A day in the life of a business owner, page 32

“To fully recognise the highly-skilled workforce in optometric practice, enabling them to deliver optimal first contact accessible eye care and continuity of care for their local community.”
Zoe Richmond, clinical director of LOCSU IP special report, page 46



OT shadowed Dean Russell MP during a visit to Specsavers Watford, where he heard about the value of MECS www.optometry.co.uk/videos

Read our latest content, updated daily online: www.optometry.co.uk
OT’s Selina Powell and Laurence Derbyshire met with Optometry Wales chair, Craig MacKenzie, via Teams to learn about the “revolution going on in Wales at the moment” www.optometry.co.uk/videos

Keep up to date with all things optics by following OT’s social channels

OT’s Lucy Miller travelled to Orlando for the unveiling of Transitions’ Gen S lens www.optometry.co.uk

Professor David Whitaker received the AOP’s Lifetime Achievement Award in front of more than 150 guests at the Association’s Excellence in eye care event. Turn to page 90 www.optometry.co.uk/videos
....................................................................................
1
OT’s latest CPD Video explores fitting scleral lenses with Dr Jason Jedlicka www.optometry.co.uk/cpd
2
100% success
Find out what happened at 100% Optical on OT’s digital hub www.optometry.co.uk/ 100-percent-optical
3
The latest guest to sit down for The OT Podcast is Dame Mary Perkins, who talks about her career www.optometry.co.uk/podcasts
4
Insight into patients being removed from wait lists and placed on active monitoring www.optometry.co.uk

OT finds out how political engagement can catalyse change for patients and the profession

At the Institute for Government conference a banner reads: “We don’t predict the future, we help you shape it.”
Karin Smyth
MP steps up to a podium set against a horizon-blue background and outlines the current challenges facing the NHS.
The Labour shadow health minister and former NHS manager outlined how 619,000 patients are waiting for eye care treatment –including 17,000 people who have been on the waiting list for more than a year.
“Patients are left with a desperate choice: wait and risk losing their eyesight, or pay to go private. There is a two-tier health system emerging,” she highlights.
In an exclusive interview with OT in February, Smyth highlighted the impact that delays in treatment have on patients.
“What we see is these terrible waiting lists – each one is really anxiety-inducing for the individual and their family,” she said.
“We really want to see that change and we think the use of the High Street optometrist is a way to help tackle that problem,” Smyth emphasised.
Smyth, who visited Specsavers Kingswood at the end of January, highlighted the importance of accessibility when it comes to healthcare.
Ò Prevention, as we all know, is much better than having to cure a condition further down the track
Karin Smyth MP
At the January conference, Smyth described how optometry practices, with their specialist staff and equipment, could play an important role in easing the burden on hospitals. “To be an outpatient, you shouldn’t have to go into hospital. The clue really is in the name,” she highlighted.
Concrete details about how this transfer of care would be implemented – for example, funding and the specific conditions that would be treated – have not been set out.
However, the fact that optometry is being discussed at all is, of itself, a type of political sea-change. Prominent campaigns – such as Sight won’t wait and The Eyes Have It – have brought eye care into focus nationally and amplified the voices of the professionals who deliver that care.
Hansard records show that between 2021–2023 there were more mentions of optometry in Parliament than every reference to the profession in the preceding decade combined.
“Prevention, as we all know, is much better than having to cure a condition further down the track. Finding problems early is, in the long term, a better way of reducing those waiting lists and actually reducing costs in the system,” she shared with OT.
When asked how Labour would implement change if elected to government, Smyth highlighted the importance of establishing the services optometrists can deliver.
“We would need to work with the profession so that people can operate at the extent of their licence,” she emphasised.
When asked about funding, Smyth shared that this would form part of negotiations with the sector.
She acknowledged variation in how eye care is offered across the UK. “We know that different health systems are operating differently. Some are very advanced and we wouldn’t want to take those areas backwards. It is a case of working out what is working best across the country,” Smyth shared.
“We’d want to understand where there are particular problems. But where things are moving at pace, we would want to support that and learn from it,” she said.


Smyth confirmed that establishing connectivity between primary and secondary care is a priority for Labour.
“The interoperability between primary and secondary care is a key issue for how we reform the health service across all specialties,” she said.
“There are good examples where that’s working well, but that is not happening enough across all parts of the sector,” Smyth said.
Experience as an NHS manager has informed Smyth’s approach as a politician.
She helped to set up a referral management service in Bristol, which included collaboration with ophthalmology.
“I have insight into some of these longstanding issues. And I think I do bring that to the piece. I know how difficult it is to change systems, to support good practice and then
spread it,” she said. “I hope to help people across the country have a better NHS,” Smyth concluded.
After working as an optometrist for more than three decades, AOP chairman, Emma Spofforth, has heard many promises from politicians wearing an array of different coloured rosettes.
However, she has met Smyth’s plans to deliver more care in High Street optometry practices with cautious optimism.
“I think what we ought to really do is acknowledge the fact that it has been said openly,” she said.
“We’ve done a lot of work engaging politically, and it clearly has made a difference. The idea is absolutely brilliant – as long as there’s money to support that.”
Over the course of her career, Spofforth has observed optometry
enter the national spotlight during periods of change for the profession – such as deregulation and the removal of free universal sight tests in England.
“I think, historically, we have been reactive as a profession whereas now we are much more proactive.”
A key force for change has been Battersea MP Marsha de Cordova’s
 Karin Smyth MP, shadow health minister
Karin Smyth MP, shadow health minister



“
England is the only country in the UK without an eye health
drive to establish a national strategy for eye care within England.
Introducing the strategy in November 2022, de Cordova drew attention to a postcode lottery in service provision. Addressing MPs in May 2023, she shared: “England is the only country in the UK without an eye health strategy.”
“The benefits would transform lives, alleviate pressure on health services and reduce economic costs. Our goal should be to ensure that no
one loses their sight unnecessarily,” she said.
A Freedom of Information Act request by Optometry Today to NHS England in February 2023 revealed that, since 2019, there have been 551 reports of patients losing their sight as a result of treatment delays.
Spofforth shared that many optometrists are witnessing first-hand the effects of delays in treatment. She added that an optometry practice is often more
accessible than a hospital eye clinic for patients with concerns about worsening symptoms.
“It’s a big issue. A lot of optometrists will struggle to help the patients who come to them,” she said.
Alongside treatment delays, Spofforth put forward funding concerns and connectivity challenges as key issues for optometry within England. She highlighted that the General Ophthalmic Services fee has not kept pace with advances in technology and the level of service that optometrists offer.
Spofforth believes that establishing a reliable and consistent method for sharing information between optometry practices and secondary care would help to reduce unnecessary referrals. “Far too few optometrists get an outcome letter after their


referral,” Spofforth observed. “If you’ve got decent connectivity set up, there’s a two-way transfer of information. That helps the individual optometrist to learn and it can prevent referrals in the future,” she said.
Spofforth points to negotiations in Scotland and Wales as examples of how political engagement has resulted in tangible change for optometrists working in practice.
“They stood up, they’ve been counted, and they produced change. We’ve seen the benefits that have occurred as a result,” she said.
Public awareness of optometry has increased over time. For example, every year since 2015, the General Optical Council has asked 2000 members of the public where they would go if they woke up with an eye problem. Last year, for the first time, optometry was the most popular choice across the UK
(selected by 36% of respondents), followed by a GP practice (33%).
There remain stark differences in an individual’s answer depending on whether they live in Scotland, Northern Ireland, Wales and England – with 46%, 49%, 39% and 30% of residents, respectively, selecting optometry as their first port of call.
When judging how political engagement strengthened the optical sector in Scotland, an obvious place to start is funding.
Up until 2021, the optical sector was the only primary care provider in Scotland that did not have an annual fee review process.
Negotiations spearheaded by Optometry Scotland saw the profession go from a decade without an increase in the primary eye examination fee, to successive annual uplifts culminating in a 6% rise for 2022–2023.
When asked how she has approached negotiations, Optometry Scotland chair, Julie Mosgrove, emphasised the importance of taking a constructive approach.
“I think it’s very easy for us to focus on what isn’t working. But I think what becomes more exciting is the problem-solving aspect: how do we overcome those challenges to improve things for the future? It’s a good news story, but there is an
Julie Mosgrove
“
If we don’t fix it today, can we fix it tomorrow?
Julie Mosgrove
opportunity to improve it,” she shared. “As optometrists, we can slip into jargon, but it’s important to keep the message simple and clear,” she said.
Mosgrove shared that engagement with area, regional and local optical committees can help to drive the profession forward. “That’s how I first got involved. I was looking at the challenges and opportunities within Grampian eye care, and then from there, moved on to supporting what we could do nationally in Scotland,” she said.
These committees provide optometrists with the opportunity to share the challenges they are facing every day and come up with solutions. “You can come up with a collective suggestion that can help drive things forward or make the patient experience better,” Mosgrove observed.
The pace of change and issues around funding can create frustration working in optical politics. But Mosgrove endeavours to keep the bigger picture in mind.
“If we don’t fix it today, can we fix it tomorrow? I think that’s probably what drives me to keep going,” she said.
In Scotland, around four in 10 optometrists have their independent prescribing (IP) qualification. There are currently plans to incorporate IP into the undergraduate course.
Mosgrove shared that there remains uncertainty in Scotland about how the Education and Training Requirements will be implemented – for example, the level of funding that will be allocated to universities and how employers will be supported to deliver placements.
Aligned to the changes in universities is another key issue that Optometry Scotland will focus on in 2024 – identifying current workforce capacity and how this might need to change to meet future demand.
“There are many people who have gone down to part-time or flexible working – that’s a big change,” Mosgrove said. “It’s not just people towards the end of the career. It’s people coming in fresh into the career looking to do four days rather than five,” she added.
A planned workforce survey would quantify not only how many optometrists are working in Scotland, but the number of days they are working in practice and their mid to long-term career plans.
This information will be particularly pertinent in the context of demographic changes in Scotland and across the UK.
“If we have fewer people coming through, or if we have people coming through but working fewer hours, that’s going to make a big difference when we’re a growing, ageing population needing eye examinations,” Mosgrove highlighted.
In Wales, a new national contract that came into effect in October 2023 will see more patients turn to optometry practices for care that has traditionally been delivered in hospitals. Greater financial recognition of clinical skills can be seen in a sight test fee that has more than doubled, while the skills of optometrists with higher qualifications are acknowledged
through a higher fee for specialist services. Optometrists will take on greater levels of low vision work in the community – including, in a UK-first, optometrists with specific qualifications certifying vision impairment.
By this month (April), pathways will be in place for optometrists to deliver glaucoma and macular services in the community.
Optometry Wales chair, Craig MacKenzie, who spoke to OT after a morning removing metal from a man’s eye following a welding accident, shared that attendance at his regional optometric committee (ROC) has doubled following the contract negotiations.
“There is a revolution going on in Wales at the moment,” he said.
“What we’re seeing is lots of optometrists upskilling and investing their time to be able to deliver services in the community. We’re seeing practices and practice owners investing in their practice equipment, and training their staff in order to deliver the services,” MacKenzie shared.
The optometrist first became involved in an ROC when he took over his practice – Specsavers Newport – in 2012.
He has observed first-hand the benefit of extended services for patients through a glaucoma referral refinement pilot that began at his practice in 2014.
Since 2016, his practice has acted as an ophthalmic diagnostic treatment centre for patients with symptoms of wet age-related macular degeneration. Through his involvement in Optometry Wales, MacKenzie has approached the question of how to provide a consistent level of service nationally.
“Different health boards were running various different systems and schemes, but they were locally tendered and locally run. There was no uniformity necessarily,” he said.
“
There is a revolution going on in Wales at the moment

“We wanted to be able to deliver these services consistently for the betterment of the people of Wales.”
“To be able to see these services rolled out across Wales is really satisfying for me, because I know how well it can work,” MacKenzie emphasised.
The optometrist acknowledges that there were challenges in negotiating a national contract that took into account the interests of all practitioners and their patients.
“We didn’t get the domiciliary provision right,” he said.
“When we went through the consultation process, we were hearing from domiciliary providers, ‘This can’t work because of X, Y and Z’,” MacKenzie shared.
After taking this feedback on board, Optometry Wales went back to the Welsh Government with updated provisions that took domiciliary concerns into
Alex Lloyd Jenkins
account. MacKenzie highlighted that Optometry Wales also worked to address why the domiciliary viewpoint had been overlooked.
“We weren’t hearing the voice of domiciliary providers as loudly as we should have been,” he said. A seat for a domiciliary representative has now been established in ROCs across Wales.
Through the contract reforms in Wales, dispensing opticians will receive a continuing professional development grant.
MacKenzie is a strong supporter of providing further training and development to the wider sector, including to dispensing opticians and optical assistants. “We need to make sure that this tide is going to lift all boats,” he emphasised.
The main question mark that remains in Wales is over digital connectivity that supports the delivery of care. The Welsh
Government has committed to rolling out enhanced IT systems for optometry from 2025.
“For the optometrists and the practices that have invested their time and money into being able to deliver the services, we do need the IT infrastructure. So that for us is one of the key issues,” MacKenzie shared with OT.
Throughout his involvement in optical politics, MacKenzie has continued to work as an optometrist in practice four days a week.
“Being an optometrist, and testing on a day-to-day basis, makes me the happiest,” he said. “I do feel really privileged to be able to deliver the clinical care to the patients that come through the door,” MacKenzie shared.
He stressed the importance of optometrists becoming engaged at community level in order to deliver national change. “It really
does mean optometrists getting involved locally themselves, finding out about what can be delivered and speaking to the right people at the right time,” he shared.
“Then, hopefully, that revolution will spill across the border.”
Readanextendedversionofthis story,featuringinterviewswith vicechairofOptometryNorthern Ireland,BrianMcKeown,Peter GibsonMPandLordColinLow,on ourwebsite:www.optometry.co.uk
 Selina Powell OT features editor. Get in touch by email: selinapowell@optometry.co.uk
Selina Powell OT features editor. Get in touch by email: selinapowell@optometry.co.uk





When Craig MacKenzie took over Specsavers Newport in 2012, the town centre had one of the highest proportions of closed shops in the UK. MacKenzie has since developed a practice that offers pioneering extended care schemes, with patients stopping off to buy a coffee or browse for a jumper following their appointment. “We are symbiotic with other businesses on the High Street,” he shared with OT.
As well as contributing to the regeneration of his High Street, MacKenzie has worked to translate the extended clinical services he offers locally to a national scale. The Optometry Wales chair, who helped to spearhead a new national optometry contract in Wales, was photographed at his practice in Newport for our April/ May Politicsandpersuasionedition. “It was a fun thing to do,” MacKenzie shared. “It was also good to reflect on what has been achieved over the past few years as often we don’t,” he said.
Photographed for our cover is Marsha de Cordova MP, who for the last 18 months has been calling on the Government to establish a National Eye Health Strategy for England – the only UK devolved nation that does not have one currently. We captured de Cordova in locations across Parliament, where she is working on ensuring that her Bill is re-tabled. She hopes the Bill will ensure that “regardless of where one lives, everyone can have access to good quality eye care when and where they need it.”
Contributors Marsha de Cordova, Craig MacKenzie Photographers Louise Haywood-Schiefer, Alex Lloyd Jenkins.
You can watch our online exclusive video interview with Craig on our website by scanning the QR code here
Expertlycurated contenttailored to supportyou in youropticalstudies.
The NEWfree-to-use CooperVisionOptiStudenf" app is designedto put valuable,curatedeye care content into the handsof opticalstudentsprovidinga video libraryof high-qualitycontent acrosskey areas.
Throughthe app,studentscanalsoenter the CooperVisionOptiStudenf"Awardsan annualcompetitionthat celebrates opticalstudentsfrom acrossEurope.

Downloadfor free now.



“IT IS IMPORTANT TO SHARE KNOWLEDGE AS MUCH AS YOU CAN”
Karan Vyas, optometrist at Newmedica and AOP Councillor, tells OT about the value of getting involved and his road almost taken
I can map out the day that I decided to pursue optometry. It was results day, in August 2012. Leading up to that, I had planned to do a course in engineering at the University of York. But A-levels were gruelling, and I got to a point where I was like, ‘I don’t want to be at university for five years.’ I started Googling, and optometry came up. There was a clearing spot at Bradford, and I went for it and got in. It was all by chance.
I have a few highlights from university.
I learned a lot, and got involved in so much – including being on the committee of the optometry society, working with the AOP, and taking part in OT features.
Another highlight was setting up the Access to Eyecare charitable event. We tested the sight of those experiencing homelessness and provided them with free eye care and spectacles. That was definitely a fun project.
Graduating was a big moment. Towards your final year you do tend to push yourself quite a bit, and there’s a feeling of relief at the end, when you’re finally done.
For my pre-reg, I went to Tesco Opticians, in Hamilton, Leicester, which was a great experience. Leicester is quite diverse: it has got some really rich places, but it has also got very poor areas. I learned a huge amount that I don’t think I could have anywhere else. Pre-reg is gruelling for everyone, but actually, it was one of the best experiences and best jobs I’ve had.
About four weeks after my pre-reg ended, in 2016, I moved to Specsavers in Corby, progressing to lead optometrist. Aside from pure optometry, I helped with audits and rotas – simple things, but also a lot of the enhanced services work, sorting out contracts and that sort of thing. I was with Specsavers for eight years.
I competed my independent prescribing (IP) qualification in 2020, during lockdown. Working in practice throughout lockdown, it became increasingly clear that prescribing was going to be needed. I applied and got into Glasgow Caledonian University, and they put me through a fast-track course that was being trialled at the time. The idea was to complete the IP course in six months, which I did. I did my placement in 2021, in Leicester, and qualified as an IP optometrist in July 2021.
In 2023, I started working one day a week at Newmedia. Working in a multiple and working in a private hospital were quite different environments. Specsavers is an optometrist’s
bread and butter. Newmedica gave me the opportunity to start using some of my higher certificates and my IP training, so it expanded that side of things quite well. Also, it was really fun. It was nice to break it up a little bit, and have something different.
“Pre-reg is gruelling for everyone, but actually, it was one of the best experiences and best jobs I’ve had”
In February 2024, I left my Specsavers practice to work at Newmedica full time. I’m still working with Specsavers, doing things like creating CPD alongside the professional advancement team at head office. It’s something new and something I’ve never done before, so I want to really get my teeth into it and learn as much as I can. It has always been an area of interest. I feel like having the skill is one thing, but it is important to share knowledge as much as you can. Learning from your peers, and learning on the job, you can learn a lot more than you can from a textbook. If you deliver CPD in more innovative ways, you can get a lot more out of it.
I’m also completing my Master’s in advanced clinical practice with Moorfields Eye Hospital and the University College London. I’m midway through, so my immediate goal is to try to get through it. Life is quite intense at the moment.
NAME: Karan Vyas ROLE: Optometrist at Newmedica
LOCATION: South Lincolnshire
It has been a rollercoaster few years. I think I have been lucky, because I have had a lot of opportunities. I’ve been involved with the AOP for a long time, and I’ve worked with the College of Optometrists. Most of the time, I’ve sort of stumbled into one thing or the other. I’ve had opportunities that some people would say are very lucky.
Speaking at the 2023 Liberal Democrat party conference about optometry. For the first time ever, I felt like it was an opportunity to start a conversation. For the past 12 months, I feel like the profession has made more progress in lobbying and becoming politically engaged then I’ve seen since I started being involved with the AOP in 2012. My first time on AOP Council was in 2015 or 2016. At the time, going to conferences was seen as an expense. Now, it is seen as an essential thing that we need to do. And we’re making hay, we’re seeing progress; we’re in the room.

Frank Eperjesi tells OT about his experiences locuming in the 1990s, and returning to it four years ago
Before I started locuming... I was working at Aston University, as a lecturer. I had also previously worked as a locum for eight years, in the 1990s.
Before I became a locum, I wish I had known... I thought every practice I’d go to would have the records of every patient, but I found that it varies. In my first spell as a locum, in some practices, the patient had been six or seven times in the past, but no one could find the records. It’s less of a problem now, because many practices have electronic records.
Someone who has helped me in the world of locuming is... In one of the first practices I went to, there were two optometrists who at the time were residents, but shortly afterwards also became locum optometrists. We kept in touch, and they helped me get locum work. We would share difficult cases and they would offer advice. Their shared experiences helped me in my clinical challenges, but also helped me get work.
I made the decision to become a locum because... The first time around, I wanted to get experience of working with different methods, systems, practices, and patients.
Four years ago, I decided to go back because I wanted more freedom from the corporate nature of a big organisation.
Not having to work five days a week gives me the opportunity to do other things. I started taking DJ lessons, and I’ve just done one of my first mixes. I don’t think I’d have the time or the energy for lessons if I was working five days a week.
On my first day of locuming... I remember thinking, ‘I’ve done my pre-reg in a hospital, I know all these clinical things, but can I do a full eye exam in a practice, get the prescription right, and keep to time?’ That was one of my worries. After pre-reg, I had felt the need to branch out and get experience in community practice.
My biggest challenge as a locum is... Most of my patients are older. Sometimes, examining an older person’s eyes presents challenges: small pupils and cataracts, for example. It’s a clinical challenge, which I’m fully up for.
Some of the people I see are in their late 90s. I have the luxury of having the time to listen to their stories. Often, I’ll say to the other practice staff, ‘Oh, Mrs Smith has just told me a story about when she was a child, back in 1941, and she remembers the Blitz in London because she was living it.’
I“I started taking DJ lessons, and I’ve just done one of my first mixes”
Practices can make life easier for locums by... Having a reasonable schedule, with a reasonable examining period. Not expecting every patient to need glasses – not expecting a 90% conversion rate. Making sure the room is tidy, and the equipment is working. Allowing a decent lunch break. Being reasonable in expectations, and having the previous notes ready.
My advice for new locums is... Get to the practice in good time. Patients will be there on time. I get there 15 minutes before the day starts, so I can get set up. Plan, be there on time, be nice to the staff. And smile, when it’s appropriate.
NAME:
Frank Eperjesi
LOCATION: West Midlands
LOCUM FOR: Four years
One change I have seen whilst locuming is... When I first started, referral systems were the same. Now, they vary from place to place. The practice owner or resident optometrist will know what to do.

The most important thing in my locum kit bag My retinoscope. Sometimes people are new, they don’t have records, or they’ve lost their glasses. This happens quite a lot when I’m working for Vision Care for Homeless People. The best way to start from scratch is with a retinoscope.

Important Safety Information:
ACUVUE® Contact Lenses are indicated for vision correction. As with any contact lenses, eye problems, including corneal ulcers, can develop. Some wearers may experience mild irritation, itching or discomfort. Contact lenses should not be used in case of eye infections or any other eye conditions, or in case of a systemic disease that may affect the eye. For detailed product information, including contraindications, precautions and adverse reactions, please consult the Instructions for Use on the Johnson & Johnson website: www.e-lFU.com
*Vertical heterophoria possibly caused by prism dissociation due to the presence of induced optical prism is a relevant factor for practitioners to consider when fitting toric contact lenses for monocular astigmats or those requiring a mix of toric soft contact lens designs. 4 5 Clinical studies have not been done to fully characterise the clinical effects of differences in base down prism among different contact lenses. tBased on high fit success rates, number of lenses required, and time to fit lenses during ACUVUE® Brand for ASTIGMATISM clinical studies.

References:
1. JJV Data on File 2024.ACUVUE Brand Contact Lenses for ASTIGMATISM -Overall Fitting Success, Orientation Position, Rotational Stability, and Vision Performance.
2. JJV Data on File, 2016. Design enhancements and resultant benefits of ACUVUE® OASYS 1-Day for ASTIGMATISM with Hydra Luxe® Technology contact lenses.
3. JJV Data on File 2023. Proportion Astigmats Accommodated with ACUVUE® Brand Contact Lenses for ASTIGMATISM. 4. Jackson D, Bedell HE. Vertical heterophoria and susceptibility to visually induced motion sickness. Strabismus. 2012;20(1 ):17-23.
5. duToit R, Ramke J, Brian G. Tolerance to prism induced by ready-made spectacles: setting and using a standard. Optom Vis Sci. 2007;84(11):1053-1059.
_ ··-·-·-·-·-·-·-·-·-·-·-···········-·-·-·-·-·-·-·-·-·-·-·-·-·-·-·-·-·-·-·-·-·-·-·-·-·-·-·-·-·-·-·-·-·-··············-·-·-·-·-·-·-·-·-·-·O
“IT’S ALL ABOUT THE LONG-TERM
Specialist optometrist and lecturer at Anglia Ruskin University, Dr Jane Macnaughton, on her passion for low vision and paediatrics
Can you describe working as a hospital optometrist in one sentence?
Challenging, but very rewarding.
How long have you worked as a hospital optometrist?
I’ve been in hospital optometry since my pre-reg. I qualified in 1990. I stayed at Moorfields for several years full-time afterwards, then moved to Scotland briefly when my dad died, and then came back. For the past 15 years I have been part-time. I’ve always mixed it with teaching.
You also teach at Anglia Ruskin University. How does that balance with your hospital work?
I enjoy being able to tell students about what hospital optometry is. I’m one of two hospital optometrists in my department. We teach the students how to work in primary care, but we also need to explain to them what happens after they refer their patients into hospital optometry.
What is the biggest challenge facing hospital optometry currently?
We need to upskill, which most of us in the hospital have already done. I don’t want it to become too disparate from primary care, though. Primary care optometrists need to upskill so they can take a lot of the burden from hospital optometry, whilst within hospital optometry we need to upskill to be able to do a lot of the procedures, because there are not enough ophthalmologists. It’s all about the long-term care of that patient within the system. Glaucoma monitoring and diabetes monitoring can be done in practices.
Has your experience working on the High Street benefited your hospital role?
Very much so, because it meant I could see it from the other perspective. I worked as a locum on the High Street, off and on, until about 15 years ago. In the hospital I work primarily in paediatrics and low vision. In the paediatric clinic, I can see how we need to improve our referrals from primary care. Having worked in both primary and secondary care, I can see how it could be improved. Seeing the whole process, from one end to the other, has been a great advantage.

What is hospital optometry’s biggest success in the last three years and why?
The majority of optometrists working in our department are now working in different disciplines, and are able to support a service in a far greater capacity than we could 10 years ago.
What is your biggest success in the last three years and why?
NAME:
Dr Jane Macnaughton
ROLE:
Specialist optometrist at Leicester Royal Infirmary
LOCATION:
Leicestershire
Being a keynote speaker at the Hospital and Specialty Optometrists Conference (HSOC). I was able to review how low vision services have improved over the past 30 years, and how they have become more interdisciplinary and holistic. It was huge for me to be able to report that back.
Register your interest for the AOP’s 2024 HSOC by 12 April by visiting, https://forms.office.com/e/VxD3USeX1r
One valuable moment
We see a lot of children with learning disabilities in the hospital, and parents often think we can’t test their eyes. I saw an eight-year-old who was struggling at school. He was a moderate to high myope, and we prescribed glasses. He came back six weeks later, and his dad said, ‘What have you done to my son? The taxi driver who takes him to school has to drive more slowly now, because he’s sitting in the back seat reading every single street sign. He’s now thoroughly engaged at school. He’s calmed down. He’s less aggressive.’ That this boy was now engaging at school was an absolute joy.


“I AM ALREADY WORKING TOWARDS STAGE TWO –THIS YEAR IS FLYING BY”
Hayley Smith, pre-reg optometrist at Peter Ivins Eye Care, tells OT why she is finding technology a vital tool as she approaches Stage two
My pre-reg has been exciting and busy, with each day bringing a range of fascinating patients.
I am fortunate to be working at Peter Ivins Eye Care, which is home to advanced equipment and technology. It has been interesting learning how to use each machine and how to integrate this into the management of patients. This has allowed me to develop new skills, including fitting complex contact lenses and managing myopia progression.
When I worked part-time in the practice during university, the complex equipment seemed daunting. However, I was able to build up my knowledge and confidence using each machine. I could get used to the equipment when I was pre-screening patients, and then discuss with the optometrist how to interpret the results.
An interest in complex contact lenses
During pre-reg, the technology has allowed me to upskill and start fitting complex contact lenses using the topographer. I have worked with colleagues to fit scleral lenses, which was
NAME: Hayley Smith
ROLE: Pre-registration optometrist at Peter Ivins Eye Care
LOCATION: Bearsden
a rewarding process as it improved the vision in keratoconous patients to levels they had not reached before. This sparked my interest in complex lenses, and I am excited to fit more of these in the future.
I have also had experience with orthokeratology lenses to correct myopia. The practice mainly uses these lenses as a form of myopia control. It has been interesting to see how effective these lenses are in slowing down the rate of myopia progression using the Myopia Master, which measures axial length. It is a fulfilling part of the job: the child is happy to be able to continue with their sports and activities as normal, and the parents are extremely thankful and relived that the lenses are working.
Using the equipment has also made me feel more confident in my diagnoses and management. I examined a patient with a branch retinal vein occlusion and, with the use of optical coherence tomography (OCT), discovered cystoid macular oedema (CMO) as a result. This was an important find, as the management of a case without CMO is slightly different to one with CMO. The OCT and fundus camera enable more in-depth discussions with my supervisor and are useful to refer back to.
I still find it difficult to break bad news to patients. It is difficult to strike the balance between being empathetic and emphasising urgency. I have improved since the start of prereg, but it is still something I am working on. I am now preparing for my Stage two visit. I had found my flow and what worked best for me when revising for Stage one visits, however Stage two is a different format, so I am having to work out which approach is best when revising the overarching competencies.
Many of the case scenarios are a good talking point with my colleagues and it will be interesting to hear how more experienced optometrists would approach them. I still can’t comprehend that I am already working towards Stage two – this year is flying by.



I am working towards… Preparing for my Visit three, in May. I am focusing on improving my clinical skills for the direct observation portion of the visit.
The thing I am looking forward to is... Getting hospital eye service experience. My supervisor has arranged for me to sit in on a low vision clinic in the coming weeks.
I found adapting to clinical technology… Difficult at the start, but that it has helped my clinical practice. Fundus photos and OCT have given me confidence in my examination. My Specsavers colleagues are being supportive as I develop my clinical skills.
Oran O’Connor is a pre-registration optometrist at Specsavers Newtownards

Enhance your patient experience and perception with the very latest technology and innovation.
06:00
My alarm is set for 6am. I start the day with gratitude, always: I’m straight up, feet on the floor, acknowledging three things I’m grateful for from yesterday.
I’m a fan of the power of positive thought. I use crystals every day. In the morning, I’ll pick a crystal and say whatever it is I am letting go of.
I’ll go out for a 5k run on Monday, Wednesday, and Friday mornings. Then I’ll be home, showered, having breakfast with my husband and son.
07:00
My husband will be off to work, and my little boy and I will mess about until 7.30am. He gets reading books from school, so we’ll read those, and then get ready. Then I’ll drop him at the childminder and make my way to my first visit of the day.
09:00
“I START THE DAY WITH GRATITUDE, ALWAYS”
Specsavers optometry director, Kirsty McLardy, talks OT through a domiciliary day that starts with an early morning run and ends with a moment of reflective journaling
I arrive at my first patient for 9am, where I am met by an optical assistant. We have a natter with the patient, and I test their eyes. I say at the end of the test: ‘ok Mrs Smith, you showed me your bifocals, you told me they’re not working for your puzzles, so we’ve decided together you’re going to have X, Y and Z. This is your optical assistant, and she’s going to help you choose the glasses.’ Then, off we pop to the next patient. We carry that on throughout the day.
12:30
We have a break wherever it fits in. I’ll text the optical assistant and say, ‘I’ve just gone past Starbucks, I’m going to whip around the drivethru, what do you fancy?’ Then we’ll have 20 minutes together before heading to the next patient.
13:00
As the optometric partner, my phone might go off throughout the day. I have a bit more responsibility, if people need
me. But because I am on the go a lot and in between patients, I have nine intervals when I can make that call.
16:30
We finish around 4.30pm. Driving home, I’ll call the retail partner and discuss what we’ve done that day, as well as any actions for the next day.
We’ll have a recap with the domiciliary team, too. If anyone has gone above and beyond, or if we’ve had a card through from a patient, we’ll share that with everybody.
17:45
I get home at quarter to six. At that point it’s phones down, and family mealtime. At the moment the favourite is pulled chicken dirty fries. It’s easy and everyone loves it, so it’s a crowd pleaser.
NAME:
Kirsty McLardy
ROLE: Optometry director at Specsavers, Manchester
2 Home Visits
LOCATION: Manchester
18:30
The little one goes in the bath at 6.30pm, at quarter to seven we do bedtime yoga, and at 7pm he’s in bed. At that point my husband has his laptop open, I have my laptop open, and we have 45 minutes to an hour where we can finish anything we need to for the day.
20:00
If it’s a Wednesday and it’s Champions League night, football will go on at eight o’clock. That’s also when we have time to relax and chat about our day.
To unwind, I listen to...
Stephen Bartlett’s Diary of a CEO podcast
If I had an unlimited budget, I would have a coffee van that arrives at the patient’s home half an hour before I do, so they can get a coffee or tea of their choice, and a cookie or cake. A lot of patients are of the generation
22:00
Before I go to bed, I journal three things I’m grateful for. I’ll also put a crystal by my bed. If it’s a new moon, that’s about inviting new things into your life: new opportunity, trying something new, or a new way of thinking. It’s a daily practice.
where, if you were ever to have visited their home, they would have straightaway wanted to put the kettle on. But now, they physically can’t. A lot of them will say, ‘you can have a drink, but I’m so sorry, you’ll have to make it yourself.’ But I don’t want them to apologise. We’re there to take care of them, not the other way round. 0
Read about Kirsty’s day in more detail online: www.optometry.co.uk/a-day-in-the-life


OT presents a clinical scenario to three IP optometrists. Here, soreness in one eye leads to suspicions of a foreign body
The scenario: An otherwise healthy mechanic in his 30s presents in practice with soreness in one eye. He explains that the soreness appeared after he cut a rusty exhaust off a car two days ago. How would you diagnose in this case, and how would you manage?
OT’s panel says...
Kevin Wallace: The obvious culprit in a case like this is metallic foreign body. These can be uncomfortable but are usually easy to find and not too difficult to remove. I’d want to know

what he was doing – particularly as the speed of impact of a foreign body is very important. If he was grinding and a fragment got into the eye this can cause a lot of damage. If it was debris falling into the eye that is less worrying. If there is any suspicion of corneal penetration, you should not attempt to remove a foreign body and should seek advice from your local eye casualty.
The main investigation will be examination of the eye with a slit lamp, using fluorescein to look for foreign body tracks. If a foreign body
is trapped under the eyelid, it leaves a characteristic pattern of stain. Instillation of a topical anaesthetic will aid in examination, and will make removal easier too. It is useful to evert the eyelids, even if you think you have found the cause. I recently saw a patient with a simple corneal foreign body but after I had removed it, I found another particle under the upper lid.
If I do find a foreign body my rule is to start with the least sharp instrument possible and escalate as required. I’m not a fan of cotton buds as they can leave fluffy debris, but have purchased foam spears, which are very useful – they’re stiff enough to pick up many foreign bodies but soft enough not to do much damage. If the foreign body is embedded in the cornea it may need to be picked off with a needle, if you are comfortable to do that. The most important point here is to hold the needle tangential to the cornea to reduce the risk of damage. I find it very helpful to use a cotton bud in the handle end of the needle – that makes it much easier to control, in the same way as a



Seidel tests were explained in the OT CPD article, Use of fluorescein in optometric practice: ”Suspected corneal or scleral trauma should be assessed using the Seidel test to determine whether there is a penetrating injury. Here, topical anaesthetic is applied to the eye, which is held open using the fingers. Fluorescein, usually with a moistened filter paper strip (10% concentration), is then applied on top of the site of the suspected corneal lesion while the patient is seated at the slit lamp, combined with blue illumination and barrier filter to improve contrast. At this stage, the fluorescein is highly concentrated, and, combined with the quenching effect, does not fluoresce, but appears dark orange. If there is a leakage, the fluid will flow or stream out across the cornea and dilute the fluorescein causing it to fluoresce, indicating a full thickness penetrating injury to the cornea. This is a positive Seidel test.”
screwdriver in the palm of your hand is more stable than one just in your fingertips.
If the foreign body is metallic then there may be a rust ring. This can be removed either carefully with a needle or with an Alger brush.
For a small foreign body no other treatment may be required following removal, but for something with a higher risk of infection I usually prescribe a few days of chloramphenicol ointment (which in cases like this could be sold or supplied by any optometrist). I warn patients that it’s the anaesthetic making them feel better just now. Once that wears off, I expect their eye to be uncomfortable again – but the ointment will help and usually they will feel much better the next day.
Ceri Smith-Jaynes: I do like the heroism of a foreign body removal. That’s a great tip, about using the cotton bud to create a handle for the needle. I like to slightly bend the very tip of the needle, so it’s a bit less pointy.
I’d add to check visual acuity before and after, and to examine the anterior chamber for activity. We have an Optomap, so I’ll take a widefield fundus image to make sure there’s no penetrating foreign body; if in doubt, dilate and use the Volk. The Seidel test is useful to check for a leaking wound – you’ll need a bit more fluorescein in than when you check for staining.
If there’s a significant corneal epithelial defect, I’ll get the patient to use chloramphenicol ointment until it’s healed and then a thick lubricant
before bed for a month or so, to help prevent a recurrent corneal erosion. The healed epithelium can be a bit weak, and I don’t want the closed lid sticking and opening the wound back up when the patient wakes up.
It’s worth finding out which optometrists in your area are competent in foreign body removal. If you have a CUES or MECS scheme, you could refer to another optometrist rather than having the patient wait in A&E or a walk-in centre.
“The main investigation will be examination of the eye with a slit lamp”
Kevin Wallace
After removing a bit of metal from his cornea, I was preaching to one patient about safety eyewear when he gave me an ironic smile; he was a lecturer in health and safety and had given the same speech many times himself.
Ankur Trivedi: A slightly curved needle is advantageous as it makes the tangential approach easier. Aside from that, I think all other points that I would make have already been covered in the advice given by Kevin and Ceri.
If you are unsure about how to manage a scenario in practice, contact regulation@aop.org.uk





sales@bibonline.co.uk


Amit Kara, optometrist and partner at Specsavers Watford, and Russell Dean, MP for Watford, discussed the need for enhanced commissioning in optometry
The value of an MP visit
Amit Kara (AK): Being locally run and operated, the main value of an MP visit is in showcasing what we do in the town of Watford. The MP gets to see what we do as an employer, gets to see how we look after people’s sight and hearing firsthand, and also how operations run.
On the face of it, someone might see an optical practice but not know the behind the scenes of what we do in terms of care, referrals, or looking after eye health. It’s useful to be able to communicate with people who can make or influence change.
Dean Russell MP (DR): The purpose of these visits is that often you get told
things that you’re not aware of. You get a real sense of the reality of issues, and the good stuff as well, which you wouldn’t normally be told about. It’s important for anyone who is in a role that requires making decisions, about the country or on local issues, to meet as many people as they can. It has been great to visit Specsavers. They are a really important part of our High Street. Chatting to the team here, I can see the passion that is brought into the role and into the work that they do.
But also, what is really at the heart of this is the community. Eyes and ears are so important to us. Especially for people who are at a vulnerable point, being able to come in and hear a
friendly voice and see a friendly face that can help and advise them, is essential. Many optometrists have a close relationship with their patients and to their customers,. That really has come across today.
The need for locally commissioned MECS AK: One of our biggest barriers, and it was nice that we got to raise it during the MP visit, is the lack of a Minor Eye Conditions Service (MECS). Not being able to offer the service, although we have the facilities and the equipment and the staff who have already got the accreditation to do so, seems like a barrier that is not needed. In the eyes of the patient, it’s just another
restriction to not be able to come and see us, and an inconvenience for them to go to hospital or secondary care, which is not always necessary.
We have expanded the practice recently, so we have the facilities to provide MECS – physical space, but also equipment. It’s a shame that there are barriers that are out of our control.
DR: I was aware [of the issues in commissioning], but I wouldn’t want to be tested [on the detail]. I have been doing a lot more on the pharmacy side, so it would be good to find out more and look at the optometry side. I am always keen to make sure those people who are embedded in our community have a voice, but also are supported in making sure that they can do what they do best, which is helping the community.
AK: We have piloted MECS in our previous stores, from scratch. We moved from East London, and in those stores, we worked on what a service might look like. Patients enjoyed the service, and found it more convenient. It saved a lot of money. We use that as an example.
The case is there, in the eyes of the patients. If it’s more convenient and easier for them, we’re less likely to miss things that might need acute care. If we can look after them in a High Street practice, we’re helping the longer-term picture of a patient
NAME: Amit Kara
not taking up a hospital space where someone with more urgent needs could be seen. There’s a bigger picture here: in the hospital, other patients are missing out.
AK: Technology is always changing. Through technology we should be able to communicate in a better way to hospitals, whether that be through our referral pathway, through our scans, or our measurements. If we can have a more transparent communication method, I believe that patient care is going to be better.
DR: Being able to ensure people can avoid future issues with their eyes is essential. During this practice visit, I was fortunate to experience one of the machines and have my own eyes tested. That highlights that technology has moved on within practices like this, to be able to look deep into the eye and identify issues that perhaps aren’t even eye health related. There might be something deeper that can be predicted, much further in advance. There is technology in terms of people who have got visual impairments, but we want to avoid that for those who can avoid it, and make sure we can spot the issues before they become a problem.
-
The AOP can support practitioners who would like to host their local MP in practice. Get in touch: communications@aop.org.uk
NAME: Dean Russell MP
ROLE: Optometrist and partner, Specsavers Watford

LOCATION: Watford

ROLE: MP for Watford
LOCATION: Watford


OT looks back at the 10th anniversary optical show
Between 24–26 February, the ExCeL Centre in London played host to the biggest optical event in the UK calendar, with more than 11,725 attendees to 100% Optical 2024.
Adam Sampson, chief executive of the AOP, commented: “Each year I come [to 100% Optical] it seems to be bigger, more vibrant, more energetic, more confident, and more imaginative.”
Thanking the organisers at Media 10, and the teams at the AOP involved in the show, Sampson added: “It is a huge success.”
Pressing topics
The programme of education was packed with opportunities to engage in continuing professional development (CPD).
Dr Ian Beasley, head of education for the AOP and OT clinical editor, explained: “The education programme at this year’s event was more popular than ever with strong attendance across more than 120 CPD sessions over the three days.”
Several key themes were evident in the presentations, with myopia management remaining a core focus for the profession.
Elizabeth Lumb, director of professional affairs for myopia management at CooperVision, delivered the Main Stage presentation with a panel featuring four of the participants of the
MiSight 1 Day clinical trial, now young adults who have experienced the benefits of myopia management.
The potential for technology in eye care, and how to harness existing equipment, were also explored.
Dr Mario Giardini, a University of Strathclyde academic, discussed how smartphones and digital displays could be harnessed to deliver eye care in the community, in his presentation: Task shifting from secondary care to the community.
Access to care, and meeting the needs of every patient, were also explored throughout the programme.
Representatives of The Eyes Have It partnership, along with the national clinical director for eye care, Louisa Wickham, discussed opportunities to prevent avoidable sight loss, and covered the call for a national strategy for eye care in England.
11,725 attendees at 100% Optical 2024
120 CPD sessions over three days
The AOP delivered a suite of education on stand throughout the show, with Wendy Steele, AOP commercial director, explaining that the sessions focused on the needs and requirements of eye care professionals in the third year of the CPD cycle.
“We’re really pleased to work with Johnson & Johnson MedTech, CooperVision, and Optos, to make sure we are delivering the right education for members,” she said.
Across the show floor, exhibitors showcased the latest products, services, and technologies.
In eyewear, Eyespace revealed its new brand, Arhlo. The new line focused on inclusivity, with gender-neutral styles utilising sustainable materials, and marked its first major launch since the company received B-Corporation certification.
The footprint of the show dedicated to contact lenses was larger than ever, as Alcon joined the event for the first time, focusing on the topic of comfort in contact lenses, and highlighting its water surface technology.
CooperVision returned for a second year, bringing the results of the Fresh Thinking campaign which kicked-off at 100% Optical 2023. On the stand, the company shared ideas from eye care professionals on how to tackle the pinch points at each stage of the contact lens patient fitting journey.
The debut of 100% Ophthalmology also saw content and products for ophthalmic teams.
A successful partnership Organisers reflected on how the optical show has grown and evolved in 10 years.
Marlon Cera-Marle, show director, told OT: “10 years in any industry doing an exhibition is a massive celebration. To be here and to see how the show has grown is amazing.”
Organisers have been focused on the growth of the show, looking at equipment and new

Buki Anthony, Alcon professional education and development lead, UK and Ireland: “This is our first time in the 10 years the show has been running. We’ve come in with an open mind, wanting to experience all that 100% Optical has to offer.”
Claire Martin, head of strategy and marketing for ophthalmic diagnostics at Zeiss: “We’ve been at 100% Optical right from the start. Anybody who is interested in eye healthcare – it is for them. It’s a really important show for us.”
Emily Andrews, product director at Eyespace: “It is very exciting and coincides with our 10-year anniversary. I remember our first 100% Optical – it was a brand new show and we weren’t sure what it was going to be like, but the stand was packed the whole time. It’s great to see that continue and the show going from strength to strength.”
Kate Stockwell, head of marketing at Johnson & Johnson MedTech: “It’s an absolute pleasure to be at the event, we’re delighted to be here, and there’s a real buzz of connections.”
Alan Pitcher, commercial director for wholesale lenses at EssilorLuxottica: “100% Optical is that opportunity once a year to meet all of the professionals, entrepreneurs and key players in this industry.”
technologies, and exploring how fashion pushes forward into sustainability.
Steele reflected: “For a lot of the team who were here for the first show, it is really special to be recognising the 10th year because we know that the AOP has had such an integral part in its success, having worked on the show in partnership with Media 10 since its inception.”
“The fact we can celebrate the success together and talk to what the next 10 years looks like for this partnership, is something quite special,” she added.
Recognising the success of the collaboration, Media 10, the AOP and OT have confirmed the partnership will be extended for three years.
As official UK media partner to the show, OT has produced a suite of news and interviews from 100% Optical on a dedicated digital hub. Read more at: www.optometry.co.uk/100-percent-optical
To all members of the Association of Optometrists (AOP). This year the AGM of the AOP will be at the AOP’s office: 2 Woodbridge Street, London EC1R 0DG on Wednesday 5 June, commencing at 9am.
1. Introduction by the chairman
2. To receive and approve the minutes of the last Annual General Meeting held on 7 June 2023
3. Roll of deceased members
4. To receive the chairman’s report
5. To receive the chairman of Finance Committee’s report
6. To approve the Annual Financial Report and Accounts for the year ended 31 December 2023
7. To consider and, if thought correct, approve the proposal of the Board that BDO LLP be re-appointed as the Association’s auditors
8. Any other business.
By Order of the Directors. Adam Sampson, chief executive, 2 Woodbridge Street, London EC1R ODG.
As we enter the last year of the current three-year CPD cycle, the AOP highlights what education it will provide members through events and OT in 2024
ThisyeartheAOP,in partnershipwithOT,will hostmorethemededucation daysthaneverbefore. Themeshavebeenselectedin responsetofeedbackinthe AOP’s2023membersurvey. Thisyear,fivethemed webinardayswillcover: paediatrics(21April),myopia (12May),locuming(23June), dryeye(14July),andOCT (6October).Tocomplement, theAOPwillhost10online peerreviewsthroughoutthe year,aswellasdiscussion workshops,runboth
independentlyandin collaborationwithpartners includingJohnson&Johnson MedTech,andAlcon.
Face-to-face
Arangeofin-personevents willberunacrosstheUK, featuringone-offpeer reviewsanddiscussion workshops,aswellasthe returnofpopularlocum clinicalskillsandcareer breakconferences.
Professionaldevelopment one-dayCPDworkshopswill focuson:mastering workplacecommunication,
1. Please note that a full set of the 2023 accounts will be available at www.aop.org.uk in advance of the AGM
2. A member entitled to attend and vote at the meeting convened by the notice set out above is entitled to appoint a proxy to exercise all or any of their rights to attend and speak and vote in their place. A proxy need not be a member of the Association
3. A form of proxy is available on the AOP website (bit.ly/43BwtSD). To be effective, the instrument for appointing a proxy must be deposited with the Association’s chief executive at the Association’s office (janicephillips@aop.org.uk) no later than 3.45pm on Friday 31 May 2024. Completion of the proxy does not preclude a member from subsequently attending and voting at the meeting in person if they so wish.
The AOP’s Annual Report will be available at: www.aop.org.uk THEMED DAYS
managingteams,and developingandusing confidentbehaviour.
Continuingtosupport membersthroughasuiteof onlineeducation,OTwill provide24articles,12clinical interpretation,andseven CPDvideoexamsthroughits website.Createdespeciallyto helpguidemembersthrough thefinalstagesoftheCPD cycle,OTwillreleasea survivalpackinSeptember. Featuringsixarticlesandone video,thepackwillcoverthe domainsrequiredbyall practitionertypes.
TheAOPacknowledgesthat non-CPDprofessional advancementisalso
Five online themed days, providing interactive CPD points
importantandwillprovidea seriesofonlinewellbeing webinarsthatwillbeopen formembersandtheirwider practiceteams. OTwillalso buildonitsonlinePractice teamtraining,deliveredin partnershipwithJohnson& JohnsonMedTech.










Marsha de Cordova MP emphasised the value and potential of High Street optometry during an AOP-hosted roundtable discussion with practitioners in her constituency
WORDS: LUCY MILLER
With the aim of understanding what the primary eye care situation is like locally, the AOP hosted a practice visit and roundtable discussion with Marsha de Cordova, MP for Battersea, and local practitioners in Clapham Junction in January.
In attendance were optometrists Karen Lockyer, who has practised in the constituency since 1994 and owns the eponymous practice where the
roundtable was hosted; Indy Ghuman, who works at Moorfields Eye Hospital and locums in Battersea; Henna Ali, vice chair of the Merton, Sutton and Wandsworth Local Optical Committee (LOC); Graham Tritton, general manager at Specsavers on Northcote Road, and AOP professional and clinical director, Dr Peter Hampson.
“I really value the role that community optometrists play in delivering eye health care for people, and I’d like to see more of that happening,” de Cordova said, before the gathered practitioners

launched into a discussion that encompassed consistency of service, effective triage, integrated care boards (ICB), myopia management funding, and the potential for technology in home monitoring for certain conditions.
So, what challenges – and importantly, what solutions – were identified? OT summerises the key topics of conversation...
1Consistency of service
Tritton highlighted that if a patient who lives in Chelsea walks into his Clapham Junction Specsavers, they are not entitled to NHS treatment – even though they might live less than two miles away.
“It shouldn’t be post-coded,” he said, noting that “if you have an injury and you arrive at a walk-in centre, you can get looked after.”
De Cordova acknowledged that this disparity is down to the way that eye care services are commissioned through different ICBs. Stepping just a couple of miles out of their local area could mean that a patient is denied NHS services.
Ghuman said that inconsistency is a challenge faced in secondary care optometry, too.
“When we [at Moorfields] receive referrals from lots of different clinics, often it’s quite clunky and we have missing information,” he said. “We have to piece together information ourselves from the patient.”
He added: “It would be really good if there was consistency across the board, so it was easy for the patient to be referred, but also to make our jobs a bit more fluent in the care that we deliver to the patient.”
One potential solution is digital connectivity, a key AOP policy ask.
Ghuman said: “There is discussion around the digitisation of referrals and making it more connected, not only in the local area, but nationally as well. What I envisage for the future is more collaborative care throughout England.”
Ali noted that this difference in quality of referrals is even seen across her own LOC area, with variations across the three South West London boroughs that it covers.
“The main challenges revolve around communication between primary and secondary care,” Ali said. “Where a patient may have gone to one practice one year and then two years later to a different practice, if someone has been referred for the same condition, an optometrist wouldn’t know, because there’s no

communication. You have repeated referral.”
Three areas of London – Sutton, Kingston and Richmond – do not have electronic referrals in place at all, Ali shared, emphasising: “There’s that inequality, even just in that small area of London.”
ICB funding is key to progress
Ali warned that, “in South West London, the [ICB] deficit is growing. Funding is a major issue.”
Optometry First – the model of optometry being the first port of call for all eye conditions – would free up time in ophthalmology clinics, leaving ophthalmologists to see more complex cases, she said. Community optometrists could potentially see stable glaucoma cases and test for fluid in wet age-related macular degeneration cases, Ali believes – “but obviously, that does come at a cost.”
When it comes to ICBs, de Cordova agreed that “how we negotiate the best relationship with the Optometry First model is something that needs to be looked at closely.”
Hampson noted that, while having more funding would likely solve the problem, it can also be useful to have a champion within the ICB who understands why eye health should be a priority.
“It’s having somebody within each ICB, pushing that message and making sure everybody understands the benefit that it can bring,” he said.

3
Stable glaucoma patients could be moved into the community
Ghuman works in a glaucoma clinic at Moorfields, where patients have been moved on from the consultant because they have been deemed to be stable.
Optometrists in the clinic monitor the patient, take scans, and ask about symptoms, Ghuman said.
He believes that this work could be done more locally to the patients’ homes, if a funding model and a referral pathway existed.
He explained that some patients can be with this clinic for years, often at great inconvenience.
One patient had come to Moorfields from Oxford and was distressed because she had missed her train home, Ghuman said. He explained that his only solution was to write to her GP and ask for a referral to Oxford Eye Hospital instead.
He believes that his time would be better spent seeing more urgent local cases, and that this kind of work should be seen outside the hospital.
“We use all the same equipment. It can be done in the community,” Ghuman said.
The practitioners acknowledged that the extension of further and enhanced services and the upskilling of the profession cannot only come from optometrists themselves.
Tritton revealed that the optometrists in his practice “are chomping at the bit to get more involved. They love doing the training; they love seeing diverse cases on a day-by-day basis. It’s a resource that is just waiting to go.”
De Cordova agreed, adding that upfront costs would lead to “certain benefit as time goes on.”
Ghuman added: “Practitioners have the skills. They’re eager to develop, they’re eager to study more. With the changes to education for new optometrists, we’re going more clinical, but we need the way forward, to use that from the top down. We’re here to help.”
The need for myopia management funding
Lockyer noted that the NHS currently is not paying enough attention to the need for myopia management interventions. “We are looking at children, to try and prevent this myopia epidemic,” she said. “In children, we can control or slow down myopia progression. If you don’t slow it down, when they get older you have this whole catastrophe approaching: people with retinal detachments, macular degeneration, glaucoma.”
She added: “Interventions are expensive at the moment. Why should it be that only people who can afford it have the interventions?”
Tritton spoke about a mother who came into his practice with her five-year-old, who was already a high myope. “We spoke about myopia management and she genuinely couldn’t afford it, which broke her heart,” he said. “She ended up with the grandparents funding it, and we did it at a cheaper price, just to do what we could. So, it cost us, as well.”
“The NHS can fund it better,” Lockyer believes.
6
Better systems come from people power
De Cordova acknowledged that statistics when it comes to eye health and sight loss are staggering.
“Pretty much anyone you speak to you will know somebody who has had an issue with their eyesight,” she said. “By 2050, they estimate four million people living with sight loss. That’s huge.”
She added: “To try and ensure that we can prevent as much of those avoidable sight conditions as possible is going to be crucial. That’s where you all have a role to play. We have to keep pressing.”
• The AOP has a created a guide to lobbying, to help optometrists who want to get in touch with their local MP: www.aop.org.uk/lobbying
• The AOP is encouraging members to contact their MP as part of its Sight won’t wait campaign: www.aop.org.uk/sightwontwait
• If you are interested in hosting an MP, get in touch with communications@aop.org.uk
Watch OT’s video from the roundtable: www.optometry.co.uk/videos


Since OT launched its Special Report series on the independent prescribing (IP) workforce, the wheels of change have continued to turn. In the last year alone, optometry in the UK has seen the roll-out of new contracts, innovation in education, and work to improve consistency in minor and urgent eye care services. Each change brings a new dimension to the IP discussion and for this report, OT heard insight from representatives in England, Wales and Scotland on what these changes might bring for those working towards, or who currently hold, the qualification.
Enacted on 20 October 2023, the Optometry Contract Reform in Wales saw the formation of five levels of Welsh General Ophthalmic Services (WGOS) relating to core services for optometry practices and opt-in services that require the completion of additional clinical qualifications.
Sharon Beatty, optometrist and clinical adviser for Optometry Wales, told OT that the organisation negotiated for an Independent Prescribing Optometry Service (IPOS) as part of the national reform. IPOS was originally established in three health boards in 2020.
“I was fortunate to be involved with establishing the service with four wonderful IP optometrists in Cardiff and Vale University Health Board,” Beatty explained. Research demonstrated that 92% of patients attending the service did not require onward referral to the hospital eye service.
“The service brought immediate benefits to patients, optometry, and GP practices, and the hospital eye service,” she added.
As of mid-March 2024, WGOS level 5 IPOS Urgent became operational in all seven health boards in Wales.
This service enables non-IP practitioners to refer, following a WGOS 2 (urgent eye examination), to an IP practitioner where this is appropriate. Both intrapractice and inter-practice referrals are supported under the service.
In a webinar introduction to WGOS 5 IPOS Urgent by the NHS Wales Shared Services Partnership,
the service was described as a “precious limited resource” requiring triage at WGOS 2 level (previously Eye Health Examination Wales).
Patients are directed to attend their own optometry practice for urgent eye problems under the WGOS 2 urgent eye care appointment. At this stage, if a non-IP optometrist determines that an IP assessment is required, a referral is made.
The pathway aims to reduce demand on secondary care by filtering out those patients who can be managed by IP optometrists.
Beatty added: “There will be a formal addition shortly to the WGOS 5 clinical manual to specify the IPOS Discharge service, which means that the patients who do actually require hospital treatment can be discharged from the hospital eye service sooner to an IP optometrist as part of WGOS 5.”
Describing the “steady” introduction of this pathway across Wales, she explained: “Optometry Wales has been delighted with the engagement between practices, health boards, regional optical committees and the Welsh Government to ensure that this change has been manageable for practices, hospitals and patients.”
“All stakeholders have agreed a national approach to the service specifications to ensure consistency for practices and patients,” Beatty added.
Practices engaged in the pathway are able to manage their diaries in a way that best suits their business, informing the health board of the day or days they are available to receive referrals from other practices.
Through the pathway, the IP examination is supported by a fee for the initial assessment and any follow-up assessments required.
Beatty explained that, as part of the Optometry Contract Reform, there is an agreement for an ongoing future quarterly payment to all practices as part of quality assurance.
“Optometry Wales is liaising with stakeholders to ensure that future quality assurance mechanisms are workable for busy practices,” she said. “Health Education and Improvement Wales is overseeing the optional offer of funded Silver Quality Improvement training for practices, which includes completion of quality improvement projects.”
Reflecting on what is ahead, Beatty commented: “We are really excited about the future of IP in optometry in Wales. The support from the profession has been outstanding. All IP optometrists can now fully utilise their advanced skills to work at the top of their clinical licence so that patients can access this service across Wales.”
“The support from ophthalmology colleagues and the Welsh Government has also been instrumental in services evolving for the benefit of the citizens in Wales,” she added.
Accessing clinical placements in pusuit of the IP qualification has proven to be a hurdle for many.
NHS Education for Scotland (NES) has been exploring the applications of simulation technology in healthcare training, and identified postgraduate independent prescribing as an area of optometry that could stand to benefit from the approach.
Senior specialist lead, Erica CampbellWalker, who is also an AOP Councillor, leads the workstream. She explained to OT: “Optometrists were wanting to upskill during COVID-19, so a lot of
rWe are excited about the future of IP in optometry in Wales
SharonBeatty, optometrist and clinical adviser for Optometry Wales
them had been completing the IP training and there was a backlog in accessing clinical placements.”
NES already facilitates Teach and Treat clinics that support IP placements, and simulation offers an additional avenue for training opportunities.
Dr Lesley Rousselet, associate director of optometry at NES, identified that with growing challenges in hospital eye departments securing placements had become “harder than ever.”
Simulation offers a high quality IP training experience, the team shared. A Haag-Streit UK EyeSi Slit Lamp Simulator, with pre-programmed clinical conditions, along with a professional actor to support scenario building, enables IP trainees to examine and manage specific eye conditions in a safe, quality assured environment, with no burden on ophthalmology clinics.
“If you have an ocular emergency coming in, the practitioner can’t necessarily take the time to talk trainees through everything. This is a safe environment for learning,” Campbell-Walker said.
The benefit of simulation is that the complexity of the case can be adjusted. She added: “This supports learning, providing a safe place to practise new skills, have discussions, and try new communication styles.”
During the simulation experience, a group of three trainee IP optometrists enter a case history conversation with a professional actor playing the role of a “patient.” The actor is briefed on the information they will share, what details to hold back, and the emotions to portray.
The group then spend time with an IP optometrist facilitator, examining the eye condition presented through the EyeSi slit lamp, deciding on a differential diagnosis and developing a management plan to deliver to the patient.
Some scenarios are straightforward, to ease optometrists into the new way of learning, while others are designed to present a higher degree of challenge, Campbell-Walker shared: “Some of the “patients” will not agree with the management plans, so the optometrist gains experience of considering how to work with the patient to find something that will suit their needs in order to achieve buy-in.”
The training is followed by a debrief incorporating feedback from the actor on communication, rapport, and any history details missed, as well as guidance from the IP facilitator on clinical skills and the management plan.
Peers are also encouraged to provide feedback to each other and reflect on their experience.
Currently, the simulation training is delivered as six day-long sessions, equalling 12 of the clinical placements required for the College of Optometrists’ logbook.
Campbell-Walker explained that the next stage of the project is to explore how simulation technology can be expanded to remote and rural areas of Scotland. In the meantime, NES is also establishing a faculty of accredited educators to facilitate these training sessions.
Dr Kathy Morrison, associate director of optometry at NES, explained that in looking across the NES Clinical Skills Managed Education Network: “We’ve known for some time that simulation was being widely used in other healthcare professions – and used really well – as a safe, educational tool that is evidence-based, and that we, as a profession, seemed to be playing catch-up on.”
Introducing simulation into IP and NES Glaucoma Award Training, is just the start of the potential for eye care. Reflecting on the potential for the technology, Campbell-Walker added: “There is not really a limit of what we can cover. We are only at the very, very start because the scope is so huge. We are dipping our toes in.”
Following changes to the General Optical Council’s (GOC) Education Training Requirements for optometrists, higher education institutions have been launching Master’s courses in optometry in order to meet the new requirements. Amongst several providers is an ambition to incorporate the theory surrounding IP into undergraduate provision, supporting optometrists to be one step closer to achieving the IP qualification on graduation.
Providers in Scotland may go a step further, with ambitions to include IP in a five-year Master’s degree, enabling students to register as IP optometrists on completion.
Morrison said: “Simulation allows us to develop the profession in a very safe and qualityassured way,” adding that it allows for consistency and evaluation.
Rousselet added: “We are excitedly looking forward, both expanding what we are doing specifically in optometry, but also looking for opportunities to diversify our training. In Scotland, we’ve been working at increasing the amount of training that we have together with other professional groups. There are good examples of where that is starting to happen through simulation, and it is something we will be looking to do more of.”
In the latter months of 2023, the Local Optical Committee Support Unit (LOCSU) and the Clinical Council for Eye Health Commissioning (CCEHC) were tasked with developing a national standard specification for minor and urgent eye care. The creation of this specification for Integrated Care Boards aims to improve consistency and reduce unwarranted variation in services.
As part of the development process, the working group engaged stakeholders including Local Optical Committees (LOCs) in consultations on desired improvements.
Zoe Richmond, clinical director of LOCSU, explained that the topic of access to FP10 prescription pads for optometrists with IP qualifications was a common theme raised in the feedback.
A Memorandum of Understanding regarding the reform to the optometry undergraduate degree has been formed between the Scottish Government, NHS Education for Scotland, Glasgow Caledonian University, and the University of the Highlands and Islands.
The process of considering how the courses might look has involved wide stakeholder engagement, along with insight from the profession, and work to shape the courses continues.
Speaking with OTabout the proposals, Eilidh Thomson, optometrist and vice chair of Optometry Scotland, explained that the Scottish Government saw the GOC’s mandate to change undergraduate programmes “as a way
to start from scratch and look at what we would want if we had a blank slate to start again.”
Stakeholder engagement also continues, as details of the programme, and the inclusion of IP, are worked through with the ambition of gaining GOC approval.
“Incorporating IP into the Master’s degrees is such an ambitious step. It still requires a lot of work to make it a reality,” Thomson said. “Optometry Scotland is committed to supporting and ensuring that members are engaged and prepared for the changes. Our biggest role in the process is to make sure that our members know what is coming and that they are happy with their place in the new scheme.”
“ We need to continue doing what we’re already doing really well
Zoe Richmond, clinical director of LOCSU
“Within the new standard specification, we have written that there is an expectation for optometrists working within a commissioned service who hold IP qualifications to get access to FP10 pads,” Richmond explained. “We think there will be wide benefits in making this available: benefits for the patient, the practitioner, and the system,” she added.
The expectation that IP optometrists have access to FP10 pads could improve access to treatments for patients. Richmond shared: “Through independent prescribing qualifications and increased clinical exposure, we can enhance clinical decision-making regarding patient management on the High Street. We can improve access to treatment but should remember that it’s sometimes as much about knowing when not to treat as it is being given the authority to treat.”
This inclusion was important in recognising the role of optometrists with additional qualifications within local provision.
“The involvement of optometrists with higher qualifications and experience, such as independent prescribing, should help to broaden the range of conditions that we can treat through to resolution within primary care,” Richmond said.
Setting this expectation goes beyond the provision of prescribing resources. Richmond said: “Recognising IP within the standard specification provides better recognition of their qualification and experience and, through that, their ability to offer peer support, advice, and guidance to clinical colleagues delivering within the local service.”
Through the national standard specification, it is hoped that commissioners considering services for minor and urgent eye care in the community would recognise the “whole of the workforce in primary care, including those optometrists with higher qualifications such as IP and, in fully recognising those individuals, allow them to work at the top of their licence,” she added.
The provision of the minor and urgent eye care services remains within local commissioning decisions.
“For all that we are clearer on what the process for accessing FP10s for IP optometrists looks like, there is still work to be done on the ground. By setting out the expectation in the standard specification, we have by no means brought the entire solution, but it is good to have the expectations set out very clearly,” Richmond said.
The developers also recognise that local systems bring innovation, and this is something that they hope to encourage.
“We want local stakeholders to own this, continue to innovate and develop those areas of excellence. In areas with commissioned services, we’re inviting people to review the national standard specification and look for areas of opportunity and improvement within their local service,” Richmond explained.
In those areas without existing services, it is hoped the specification will support local leaders to engage commissioners. Richmond said: “With the new specification, LOCs and local commissioners have a framework that has been co-produced by the eye care sector and clinically endorsed by the Clinical Council and Colleges, that they can have confidence in.”
Recognising that reducing variation in provision across England will take time, Richmond shared: “I hope that this is not only about reducing unwarranted variation across the existing services but reducing unwarranted variation in access. I would like to see more of the population of England have access to minor and urgent eye care on the High Street as we move forward.”
As the profession works towards this goal, she highlighted a need to gather evidence demonstrating the effectiveness of commissioned services: “To show that delivering more care in optometric practice, optimising that first contact care, not only has a benefit to the patient but to the wider system – in the service of minor and urgent eye care – alleviating some of the capacity pressure across hospital emergency departments and general practice.”
“We need to continue doing what we’re already doing really well, collate the evidence base to strengthen our cause, share best practice, and keep on improving outcomes for patients,” Richmond told OT.

EXAMS CLOSE: 1 JULY 2024
This article will consider a panoply of sleep disorders linked to common eye diseases and systemic disorders, outlining the optometrist’s perspective on management and referral.
Dr Paul Chous MA, OD, FAAOSleep problems are highly prevalent, with nearly half of the population in the US and more than half of UK residents affected each year.1,2 Episodic sleep abnormalities or parasomnias include sleepwalking (somnambulism) and sleep talking (somniloquy), sleep terror disorder and nightmare disorder. Dyssomnias – abnormalities in the amount, quality, or timing of sleep –include entities such as primary and secondary insomnia (prolonged latency falling asleep and/or short duration of sleep associated with excessive daytime sleepiness), narcolepsy, restless leg syndrome and sleep disordered breathing (obstructive, central, and mixed sleep apnoea, as well as upper airway resistance syndrome).
Importantly, untreated dyssomnias –particularly sleep apnoea, insomnia and hypersomnia (excess sleep duration) – are strongly linked to increased risk of multiple systemic and ocular diseases and poor response to treatment. This article will examine the implications of these findings and strategies for assisting patients.
Hyposomnia refers to short sleep duration, defined as fewer than seven
hours of daily sleep, is a subset of insomnia and has a prevalence of 35%. In those with severe hyposomnia (fewer than five and a half hours of daily sleep), rates of diabetes are three-fold higher in a meta-analysis of observational studies.2 Short sleep has also been linked to increased rates of myocardial infarction (MI), particularly when accompanied by daytime sleepiness.3 Hyposomnia is also associated with several ophthalmic conditions, including primary open-angle glaucoma in abdominally obese subjects,4 dry eye symptoms5,6 (possibly mediated by consequent lacrimal gland hypertrophy7 or alterations in corneal epithelial microvilli that destabilise the tear film),8 moderate myopia in adolescence9 and neovascular age-related macular degeneration (AMD).10 Recently, poor sleep quality as assessed by a validated amalgam of questions (the Pittsburgh Sleep Quality Inventory), related to the time it takes to fall to sleep (latency), short duration of sleep and wakefulness after sleep onset, was found to independently increase the risk of vision-threatening diabetic retinopathy (DR) – defined as severe non-proliferative DR, proliferative DR and diabetic macular oedema (DMO) by more than eight-fold in a matched case-control study of 126 diabetes patients.11
Conversely, hypersomnia (greater than eight to nine hours sleep) appears to be associated with insulin resistance and abdominal fat stores that increase the risk of type 2 diabetes,12 depression and other psychiatric disorders, multiple sclerosis, hypothalamic disease, untreated sleep apnoea, and intake of multiple drug classes including sedative-hypnotics, ethanol/ cannabis/opiates, muscle relaxants, beta-blockers and anti-psychotics.13 Major causes of vision loss have been connected to hypersomnia, including glaucoma (only significant in subjects with abdominal adiposity, defined as waist circumference >102cm in men and 89cm in women),4 sight-threatening DR and geographic atrophy (GA) seen in advanced non-exudative AMD.14
Observational analysis of 1231 type 2 diabetes patients in Singapore found that sleep duration in excess of eight hours coupled with symptoms of daytime sleepiness were independently associated with more than a three-fold risk of vision-threatening DR.15 The proposed mechanism for this increased risk is the fact that the majority of retinal oxygen demand is mediated by rod photoreceptors, with increasing retinal hypoxia in closed-eye conditions, a hypothesis supported by animal studies showing improved DMO with green LED stimuli through closed eyelids during sleep.16
50 Sleep disorders in the eye and related systemic disease
54 Repeated low-level red-light therapy: the future of myopia management?
Similarly, hypersomnia was associated with a greater than seven-fold increased risk for GA in a consecutive series of 1003 patients examined in a San Francisco retina specialty clinic after multivariate analysis controlling for age, gender and smoking history,14 suggesting relative, rod-mediated retinal hypoxia during sleep may also contribute to advanced dry AMD.
Regarding sleep duration, it is worth noting that several conditions cited above are associated with both short and long sleep duration, including diabetes, glaucoma and neovascular AMD. Indeed, a meta-analysis of more than 480,000 participants revealed a U-shaped pattern of diabetes prevalence in patients with very short and very long sleep duration. This analysis suggests a ‘sweet spot’ of roughly seven and a half hours of sleep for lowest diabetes risk after controls for common diabetogenic risk factors such as family history, hypertension, body mass index (BMI), and age;17,18 a similar sweet spot is seen in analyses of glaucoma4 and AMD.14,19
The mechanisms linking short and long sleep duration to diabetes risk are believed to be multifactorial, including neuro-endocrine perturbances of circadian rhythm affecting glucose metabolism.20,21 It also seems likely that many of the preceding associations are bidirectional or multifactorial; for example, obesity itself increases the risk
60 The many faces of retinitis pigmentosa
66 Dry eye disease and its impact on everyday wellbeing
of both short sleep and development of type 2 diabetes, so hyposomnia could partially or largely be a comingling variable. Similarly, vision loss from AMD or DR is known to be associated with depression, which in itself increases the probability of excess sleep.22
Obstructive sleep apnoea syndrome
Obstructive sleep apnoea syndrome (OSAS) is the sleep disorder most widely recognised as a contributor to both ocular and systemic disease. It is characterised by partial (hypopnoeic) or total (apnoeic) collapse of the airway, resulting in temporary cessation or reduction of airflow greater than 10 seconds during sleep with at least a 4% decline in red blood cell oxygen saturation.23 By contrast, central sleep apnoea refers to a neurologic deficit leading to loss of the ventilatory reflex and is far less common, although some patients have a mixed form of apnoea with both obstructive and neurogenic components. OSAS affects about 20% of the adult population, but it is asymptomatic in 85% of patients. Apnoea severity is graded by the apnoea-hypopnoea index (AHI), which represents the total number of apnoeic plus hypopnoeic events per hour of sleep (see Table 1).24
Several validated patient surveys are available to assess the risk of undiagnosed apnoea, including the Berlin Obstructive Sleep Apnea Inventory and the STOP-BANG questionnaire, which the author routinely uses in clinical practice (see Table 1).25 Definitive diagnosis depends on availability and results of polysomnography, and, of note, certified sleep study centres are 10fold more prevalent in the US versus the UK (per million residents), despite similar prevalence of OSAS in the two countries.26 Risk factors for OSAS include higher body mass index (BMI)
LEARNING OUTCOMES
Optometrists and dispensing opticians will be able to advise patients on practical sleep hygiene measures
Optometrists and dispensing opticians will recognise the link between sleep disorders and systemic and ocular comorbidities.
and neck circumference (>35kg/m2 and 40cm, respectively), airway laxity, older age, smoking, alcohol use and male gender.25 Others report that OSAS is present in 41% of patients with a BMI of >28kg/m2 . 27
Standard therapy for OSAS includes use of continuous positive airway pressure (CPAP) devices, but half of all patients discontinue therapy within the first year.23 Alternative therapies include hypoglossal neurostimulation, uvulopalatopharyngoplasty (removal of the soft palate, uvula and tonsils), customised oral appliances that advance the mandible, tongue base radiofrequency therapy and genioglossus muscle advancement. These therapies are designed to anatomically open the airway and/or improve muscle laxity. Some studies suggest that players of double-reed instruments (for example, bassoon, oboe, English horn) and didgeridoo have lower prevalence and severity
of OSAS, presumably by ameliorating muscle laxity of the upper airway.28,29
After adjusting for confounding variables, untreated OSAS increases the odds of MI and stroke by more than three-fold30 and the risk of heart failure 1.4-fold,31 presumably due to myocardial hypoxia. Severe OSAS has been associated with a 71% increased incidence of diabetes over 13 years of follow-up, independent of adiposity and other diabetogenic factors.32
Unfortunately, the investigators in this study did not track prescription of, or compliance with, CPAP therapy over study duration, leaving open the question as to whether treatment of OSAS made a difference in diabetes incidence. The mechanisms linking OSAS to diabetes are not entirely clear but may include increased inflammation, sympathetic activity, and insulin resistance because of chronic hypoxia.33 At least one study has linked OSAS to changes in intestinal microflora that modulate insulin sensitivity and resistance in humans.34 Moreover, untreated OSAS is the most common secondary finding in drug-resistant hypertension (lack of therapeutic efficacy with at least three distinct classes of blood pressure medication in combination) and apnoea is present in roughly half of hypertensive patients.35
Multiple, prevalent ocular conditions are linked to OSAS, including DR, DMO, nonarteritic anterior ischaemic optic neuropathy (NAION), normotensive glaucoma, central serous chorioretinopathy (CSCR), idiopathic intracranial hypertension (pseudotumour cerebri), retinal venous occlusion, floppy eyelid syndrome, and keratoconus.36 Putative mechanisms for these associations include increased oxidative stress with upregulation of systemic and ocular inflammation, autonomic dysfunction favouring activation of the sympathetic nervous system, endothelial dysfunction resulting in breakdown of the bloodretinal barrier and dysregulation of circadian genes. Although some of these associations are of less statistical
S Observed snoring
T Tiredness during wakeful activities
O Observed cessation of breath during sleep
P Blood pressure >135/85mmHg
B Body mass index >35kg/m2
A Age >50 years
N Neck circumference >40cm
G Male gender
High risk of undiagnosed OSAS if ‘Yes’ to ≥ three items with referral for sleep testing indicated
significance after adjustments for obesity and/or hypertension (pseudotumour, CSCR and retinal vein occlusion), patients with any of these diagnoses may benefit from referral for a sleep study to identify and treat OSAS with a goal of reducing cardiovascular and possibly ocular risk given a higher propensity for apnoea compared to the general population.
With respect to DR in particular, the evidence is rather compelling. Longitudinal analysis of OSAS in 230 participants with type 2 diabetes free of DR was associated with a five-fold increased risk of incident DR over four years.37 More specifically, an AHI greater than 11.9 compared with less than 4.8 events per hour was associated with a 7.5-fold increased risk of developing vision-threatening DR, and CPAP use decreased the hazard ratio more than 30% in this cohort. Another interesting study conducted at the Maine Veterans Affairs Medical Center in the US, representing collaboration between optometry and pulmonary specialists, showed that better CPAP compliance (greater than four hours nightly) was associated with a 46% reduced odds ratio of having DR after all controls, including glycated haemoglobin (HbA1c), disease duration, blood lipids, renal function, insulin use, BMI, smoking, and AHI.38 Another case-
control study in Taiwan linked severe OSAS to a nine-fold increased likelihood of DMO, particularly as time spent with oxygen saturation less than 90% increased.39
One important consideration is whether CPAP use improves visual acuity (VA) in patients with vision loss from DMO. A prospective study of 131 patients in the UK with DMO and severe OSAS (mean AHI of 36) receiving macular photocoagulation (baseline VA ranged from 6/12 to 6/60) showed no difference in those randomised to usual care versus usual care plus referral to a CPAP clinic at 12 months (mean VA was 6/19 in both groups).40 However, mean CPAP usage was a mere 1.7 hours, and the study lacks data on ‘gold standard’ anti-vascular endothelial growth factor (anti-VEGF) therapy for DMO. These results raise two important questions: Would an increase in CPAP use have improved outcomes? Would CPAP added to anti-VEGF therapy have been beneficial?
Collectively, these data suggest that OSAS severity is strongly linked to DR and DMO. Longer nightly use of CPAP and achieving lower AHI scores may protect against both diseases, and ‘preventative’ CPAP therapy is likely to prove more effective for preserving VA than ‘therapeutic’ CPAP use for established diabetes-related
retinal disease that impairs vision. Optometrists should ask their diabetes patients about sleep problems and consider appropriate referral to sleep medicine specialists, particularly when DR or DMO are present and when patients are clinically obese. Of note, analysis of 200 patients with type 1 diabetes consecutively assessed by polysomnography (PSG) found high rates of undiagnosed OSAS in both overweight (60%) and healthy weight (32%) participants,41 suggesting impaired peripheral autonomic neuropathy and muscle function affect the airway in these patients. PSG is the most important tool for diagnosing sleep disorders, and home-based PSG is now common, accurate, and inexpensive compared with in-clinic sleep studies, particularly for sleep apnoea.
Efficacy of anti-VEGF therapy for retinal vascular diseases also may be impacted by CPAP use. One study of neovascular AMD patients with confirmed OSAS and receiving intravitreal bevacizumab injections demonstrated improved VA in the group wearing CPAP versus those not wearing CPAP (mean 6/12 versus 6/30), reductions in central retinal thickness using optical coherence tomography (OCT) (mean difference of 78µm) and fewer injections (eight versus 16).42 In another small study of patients with DMO and PSG-confirmed OSAS, best-corrected VA improved with grid macular laser therapy by an average of one additional line using CPAP more than 2.5 hours nightly over six months.43
Adherence to and sleep-time duration of positive airway pressure therapy (PAP), whether continuous (CPAP) or variable pressure with inhalation and exhalation (BiPAP – typically used in patients with chronic obstructive pulmonary disease (COPD) to improve both oxygenation and ventilation) appears to be of great importance. The SAVE trial found that CPAP use did not significantly reduce major adverse cardiovascular events (MACE) or mortality in patients with established cardiovascular disease over a mean
follow-up of 3.7 years, but the study excluded subjects with severe oxygen desaturation and daytime sleepiness and, importantly, mean use of CPAP was a mere 3.3 hours on 70% of nights.44 Participants who demonstrated good CPAP compliance, defined as more than four hours on 70% of nights had a 44% reduction of incident stroke. Furthermore, a meta-analysis of 3780 subjects with OSAS using CPAP more than four hours nightly also revealed a significant 30% reduction in MACE.45 These data suggest a minimal effective CPAP dose of four hours for cardiovascular/cerebrovascular event prevention in patients with obstructive apnoea, a threshold that may also hold for ophthalmic disorders.
What can eye care practitioners do to assist patients with both suspected and diagnosed sleep disorders? Sleep medicine specialists recommend counselling patients about the removal of ‘local factors’ contributing to poor sleep duration and quality, including sleeping in a quiet, dark room, maintaining consistent sleep and wake times throughout the week, and avoidance of caffeine, nicotine and alcohol as sleep time approaches.46 Identifying and treating psychosocial stressors like anxiety and depression also helps, as does avoiding napping, shift work and physical inactivity, factors associated with poorer sleep quality.47
‘Light-at-night’ has received a good deal of attention in the endocrine community over the last decade, as short wavelength, blue light has been shown to suppress melatonin secretion by the pineal gland, disrupt circadian rhythm and metabolism, contributing to obesity and metabolic disorders.48 Sleep physicians commonly recommend discontinuing use of computers, tablets, phones and other blue light-emitting devices within an hour of attempted sleep, and this is something eye care
professionals can discuss with their patients. In addition, weight loss in overweight and obese patients has been shown to improve sleep quality and can be tactfully approached in clinical encounters to help reduce the odds of both obesity-related and sleep disorderrelated ocular conditions. Encouraging use of prescribed sleep therapy (CPAP, good sleep hygiene) as a method to reduce the risk of severe eye disease and vision loss may help motivate patients and even save lives.49
It is important for all health care providers to recognise the impact of sleep disorders on patient wellbeing, but also their own mental and physical function. Recent surveys have linked driver fatigue to 16%–20% of serious highway accidents in the UK, Australia, and Brazil,50 and a 2019 US analysis found that 21% of fatal motor vehicle accidents were attributable to sleepy drivers.51 Moreover, sleep deprivation, regardless of the cause, significantly increases the risk of medical errors, with surveys indicating that 40% of physicians have sleep disorders and more than a third of health care personnel report deficits in concentration with impaired decisionmaking due to sleep deprivation.52 Patients frequently ask practitioners if their poor sleep will affect the results of an eye examination. However, it is important for eye care providers to be aware of their own sleep habits to both deliver optimal care and maximise their own physical and mental health.
0
To read this article online, access the references and take the exam, visit: www.optometry.co.uk/cpd

Dr Paul Chous has a practice specialising in diabetes eye care, and is adjunct professor of optometry at Western University of Health Sciences.
Sponsored by:

This article describes the novel repeated low-level red-light therapy for myopia management and summarises the evidence base on its efficacy and safety.
Dr Rebecca Leighton PhD, BSc (Hons), MCOptom, Prof Cert Medical Ret, Prof Cert Low Vision
Introduction
The worldwide prevalence of myopia has significantly increased in recent decades,1–5 now reaching epidemic levels in East Asia.6–11 Likewise, there is a significant proportion of children with myopia in Europe, with research showing that 20% of children in the UK and Ireland will develop myopia by 12 to 13 years of age.12–15
Myopia is a progressive condition typically developing due to excessive axial elongation, which increases the risk of sight-threatening ocular pathology in later life.16,17 With the prevalence of myopia projected to affect half the world’s population by 2050,18 modern myopia research is focused on establishing efficacious and safe methods to slow the onset and progression of childhood myopia.19–24
A range of optical and pharmacological myopia control strategies have been developed and are widely being used to slow the progression of myopia.
Although not yet licensed for myopia management in the UK, low dose atropine is a popular myopia control method across the world. In China, the LAMP study, which included myopic children aged four to 12 years, reported a 12-month mean change in spherical equivalent refraction (SER) of -0.27 ±0.61D in children using 0.05% atropine compared to -0.81 ±0.53D
in children using placebo drops.25 MiSight 1 day contact lenses (CooperVision) are a commonly adopted intervention in the UK for myopia management. These dual focus contact lenses are designed to impose peripheral myopic defocus, which is understood to provide a signal to slow axial growth. A randomised controlled trial (RCT), which included children aged eight to 12 years, found a mean change in SER of -0.18 ±0.39D in those wearing MiSight 1 day contact lenses compared to -0.58 ±0.41D in controls wearing single vision spectacles (SVS) over 12 months.26 The same children were reviewed for a further two years, with the study finding that those who wore MiSight 1 day contact lenses over a total of three years, exhibited 0.73D less myopia
either SVS or single vision soft contact lenses.28
More recently, new spectacle lens technology has been developed comprising of a central optical zone to correct distance refractive error and a peripheral zone with multiple segments of relatively positive power (+3.50D) which simultaneously induce peripheral myopic defocus.29 These innovative MiYOSMART lenses (Hoya) have demonstrated a significant treatment effect in children aged eight to 13 years, with a RCT reporting a two-year mean change in SER of -0.41 ±0.06D in the intervention group compared to -0.85 ±0.08D in the SVS control group. Axial growth was 0.34mm less in the intervention group compared to controls over the intervention period.29
“THE WORLDWIDE PREVALENCE OF MYOPIA HAS SIGNIFICANTLY INCREASED IN RECENT YEARS, NOW REACHING EPIDEMIC LEVELS IN EAST ASIA”
progression and 0.32mm less axial growth than controls over this time frame.26
Orthokeratology contact lenses are also efficacious in slowing the progression of childhood myopia compared to SVS.27 A meta-analysis of seven studies including 435 children aged between six to 16 years showed that those wearing orthokeratology contact lenses over a two-year period exhibited 0.26mm less axial elongation than controls wearing
Likewise, novel Stellest lenses (Essilor) are reported to significantly slow myopia progression through the incorporation of multiple aspheric peripheral lenslets. A recent RCT found a mean two-year change in SER of -0.66 ±0.09D among eight- to 13-year-old myopes wearing this intervention compared to -1.46 ±0.09D in controls wearing SVS. Axial growth was 0.35mm less in the intervention group compared to controls.30 Promising treatment effects have 1
been seen for one-year data on SightGlass Vision Diffusion Optics Technology (DOT) spectacles lenses with mean 12-month change in SER of -0.14D for DOT lenses versus -0.54D for controls in children aged six to 10 years along with 0.15mm less axial progression reported in the intervention group.31
Over the last decade, the relationship between time outdoors and myopia has been extensively studied, and it is now well established that spending more time outdoors during childhood lowers the risk of developing myopia, and may even delay myopia progression after onset.32-36 Xiong etalconducted a meta-analysis to combine the results from multiple scientific studies and found that approximately 76 minutes of extra time spent outdoors each day conferred a 50% reduction in risk of incident childhood myopia.32 In Taiwan, a RCT assigned 1000 children to either an intervention group where they were encouraged to spend 11 hours per week outdoors, or a control group who continued their normal daily activities. After 12 months, the intervention group showed significantly less myopic change in cycloplegic refractive error compared to controls (mean change SER: intervention group -0.35 ±0.58D; controls -0.47 ±0.74D).37
In order to curb the myopia epidemic in the Eastern world, several government authorities have introduced myopia intervention protocols in their educational, health and economic policies aiming to increase the amount of time children spend outdoors.38,39 Furthermore, researchers have proposed redesigning classrooms with installations of glass walls and ceilings to increase children’s light exposure. However, these strategies are expensive and practically challenging to carry out. Therefore, the proposal of an alternative therapy that delivers light directly onto the retina for short durations to regulate myopia progression and potentially
prevent myopia development altogether is an exciting prospect.
Repeated low-level red-light (RLRL) therapy has been used for treating childhood amblyopia in China for several decades, where anecdotal reports of changes in choroidal thickness and stabilisation of axial growth led to the application of this therapy for myopia control.40 These findings resulted in the development of a specific RLRL device for myopia management. The device (Eyerising International, Australia) has been approved by medical regulators in over 30 countries across Europe and Australasia and is currently the only commercially available instrument for this purpose in the UK.
RLRL therapy is delivered by a desktop device consisting of semiconductor laser diodes which emit red light of wavelength 650nm onto the retina over short durations.41 The light power reaching the retina through a maximum 4mm pupil is 0.29mW, which is categorised as a Class 1 laser and deemed safe for direct ocular exposure.42 The device is designed to be used at home under parental supervision for three minutes, twice a day, five days a week, with at least four hours between each treatment session. Parents are required to log into the system using an assigned username and password to initiate and complete each treatment session according to the pre-defined treatment regime. Any attempts to use the device beyond this regime will be blocked, to limit concerns regarding overexposure to red light. The device is connected to the Internet which allows patient compliance data to be shared with their practitioner for use during follow-up eye examinations. One household may share a device with each child undergoing therapy having a unique login to access treatment. The device is certified as a Class IIa medical device by CE, meaning it
Optometrists and dispensing opticians will be able to explain to patients about the role of low-level red-light therapy for myopia management
Optometrists and dispensing opticians will develop an understanding of the method, efficacy and safety of low-level red-light therapy for myopia management. 0 0
complies with EU safety and health requirements. The UK’s Medicines and Healthcare products Regulatory Agency (MHRA), New Zealand’s MedSafe and Australian Therapeutic Goods Administration (TGA) have all approved the device for use in myopia control. It is classified as an American National Standards Institute (ANSI) group 1 instrument in accordance with the ANSI Z80.362021 standard. This specifically addresses the potential hazard of ophthalmic instruments used in optometry and ophthalmology fields that direct light into the eye. A group 1 classification indicates there is no potential light hazard nor thermal hazard. In comparison, the light emission from an IOLMaster biometer, which is similarly categorised as a Class 1 laser, is also deemed a Class IIa medical instrument. Interestingly, the safety instructions for the IOLMaster state that each day no more than 20 axial length measurements should be taken on each patient’s eye.43
Since its authorisation for myopia control in 2021 in China, over 100,000 children have been treated with RLRL therapy.41
The mechanisms involved in RLRL therapy are not yet fully understood
at a cellular level. However, most experimental models of myopia generally involve changes in choroidal thickness prior to axial changes, therefore the choroid is considered to play an important role in regulating refractive error.44 The choroidal blood vessels are responsible for supplying

choroidal thickening
12-months
One
RLRL
the ocular tissues with oxygen and nutrients. A recent RCT including children aged eight to 13 years showed both myopia control effects and significant choroidal thickening in eyes treated with RLRL therapy for 12 months compared to controls wearing SVS (see Figure 1).45 Scleral hypoxia has been shown to promote myopic progression,46 hence it has been hypothesised that the manner by which RLRL therapy regulates myopia progression is through increased choroidal blood flow and reduced oxidative stress, which leads to a thickened choroid, thereby slowing axial elongation.
Jiang et al conducted the first RCT investigating the efficacy of RLRL therapy on myopia progression.23 This study was based in China and assigned a total of 264 myopic children aged eight to 12 years to either an intervention group (RLRL) or a control group (SVS), with axial length change as the primary outcome measure.23 Compared to refractive measures, axial length measurements are more precise, and therefore, able to detect smaller changes in eye growth.47 After 12 months, the results showed that the mean axial growth exhibited by the intervention group was three times less than that of the control group (RLRL 0.13mm [95% CI, 0.09-0.17mm] versus SVS 0.38mm [95% CI, 0.34-0.42mm]). Likewise, the annual mean change in SER in the RLRL group was -0.20D compared to -0.79D in the SVS group. Furthermore, the more compliant the children were with the RLRL regimen, the more effective the treatment was in slowing eye growth.
A follow-up study recruited 138 children who originally completed the 12-month RCT to evaluate the efficacy of continued RLRL therapy over a longer timescale of two years.48 Children continuing RLRL therapy in the second year were defined as

“A RANGE OF OPTICAL AND PHARMACOLOGICAL MYOPIA CONTROL STRATEGIES HAVE BEEN DEVELOPED AND ARE WIDELY BEING USED TO SLOW THE PROGRESSION OF MYOPIA”
‘RLRL-RLRL’ (n=11), those who ceased RLRL therapy after one year and changed to SVS in the second year were defined as ‘RLRL-SVS’ (n=52), and those who continued to wear SVS or commenced RLRL therapy in year two were defined as ‘SVS-SVS’ (n=41) and ‘SVS-RLRL’ (n=10), respectively. As hypothesised, the smallest changes in axial length and SER over two years were exhibited by the ‘RLRL-RLRL’ group (AL 0.16 ±0.37mm; SER -0.31 ±0.79D), followed by the ‘SVS-RLRL’ group (AL 0.44 ±0.37mm; SER -0.96 ±0.70D), ‘RLRL-SVS’ (AL 0.50 ±0.28mm; SER -1.07 ±0.69D) and ‘SVS-SVS’ group (AL 0.64 ±0.29mm; SER -1.24 ±0.63D) (see Figure 2).
Interestingly, the efficacy of RLRL therapy showed a decline from the first to the second year of treatment; however, this is in line with other myopia interventions where absolute efficacy in slowing axial elongation
generally decreases after year one.48
Another RCT, published in 2023 by Chen et al, established RLRL therapy to have good efficacy in slowing axial growth and myopia progression in children aged six to 13 years compared to controls wearing SVS (mean change SER in RLRL group +0.05D [95% CI, -0.05 to 0.19D] versus SVS group -0.64D [95% CI, -0.78 to -0.51D]).49 The differences in efficacy rates between these various studies discussed may be accounted for by the differences in the ages of participants, with this particular study including younger children who may exhibit greater treatment effects.
The aforementioned studies23,48,49 investigating the efficacy of RLRL therapy were limited by an open-label design, meaning participants were not masked to the intervention they received, which can introduce bias and influence the outcomes of the
study. The first double-blind RCT also took place in China and compared the efficacy and safety of RLRL therapy to a sham device among myopic children aged seven to 12 years.50 For the sham group, the device remained the same as the treatment group but had 10% of the original device’s power. After six months, the mean change in SER was significantly less in the RLRL group (-0.06 ±0.30D) compared to sham (-0.11 ±0.33D) with respective axial length changes of 0.02 ±0.11mm and 0.13mm ±0.10mm, showing a good treatment efficacy in slowing shortterm axial growth compared with an extremely low level, that is to say, a sham device red light intervention. He et al were the first to report on the effect of RLRL therapy on myopia prevention among pre-myopic children.54 Pre-myopia is generally defined as a refractive state of -0.50D<SER≤+0.75D in children where a combination of risk factors indicate a high risk of progression to myopia.51 Hence, two groups of children (mean age 8.3 ±1.1 years) were randomly assigned to either receive RLRL therapy (mean baseline SER +0.16 ±0.28D) or act as a control group by continuing their usual activities
(mean baseline SER +0.14 ±0.30). As hypothesised, after 12 months the incidence of myopia was significant less in the RLRL group; 41% of the children using RLRL therapy became myopic during this period, compared to 61% of the control group. Hence, the relative reduction in incident myopia was 33% with the use of this novel myopia control treatment.
Overall, these studies demonstrate that RLRL therapy has good treatment efficacy for slowing axial growth and myopia progression as well as possible applications in reducing the risk of incident myopia among pre-myopic children. Likewise, most report good compliance rates with treatment, which may be viewed as a more convenient option over other established myopia control methods. However, still to be considered are the safety of treatment and the potential for rebound once treatment is ceased.
Rebound can be defined as greater myopia progression after the removal of a treatment than would have been observed had treatment not been instigated in a child of the same age.52
Xiong et al were the first to report on the effects of RLRL therapy cessation.45 As shown in Figure 2, the RLRL-SVS group showed a large myopic shift after ceasing treatment in year two (mean change SER -0.91 ±0.48D). This rate of myopia progression was greater than that observed among the SVS-SVS group in year two (mean change SER -0.54 ±0.39D), but more comparable with SVS-SVS year-one mean change in SER (-0.71 ±0.42D), suggesting a rebound effect. Overall, the SVS-SVS and RLRL-SVS groups demonstrated similar myopic shifts in refraction over the trial period. Likewise, Chen et al found children who had received RLRL therapy for 12 months exhibited an increased rate of myopic progression of -0.20D (95% CI, -0.26 to -0.14D) over the three months after cessation.49
Rebound effects have also been reported after cessation of atropine, with the aforementioned LAMP study demonstrating a larger mean myopic shift of -0.68 ±0.49D in the year following cessation of 0.05% atropine treatment among four to 12-yearolds with myopia.25 Furthermore, the LAMP study included children of younger ages compared to the Xiong etalstudy,48 therefore the latter RLRL study would have been expected to observe less myopia progression after ceasing treatment.
Hence, further research is required to establish the most suitable treatment regime, including the duration of treatment and most appropriate age to stop treatment, to mitigate these rebound effects.
The misuse of lasers, particularly laser pens described as ‘toys’ is well reported in the press and highlights safety concerns with regards to eye health. Public Health England
during RLRL treatment such as eye discomfort, pain, itching, dryness, dazzling, short-term glare, flash blindness, or afterimages was largely determined using questionnaires.23,49,50 Functional changes in vision were measured using best corrected visual acuity (BCVA) only,49 with study protocols stating that treatment would cease immediately if a child exhibited a loss of vision of more than two lines or presented with a central scotoma.23,54 In addition, structural changes to the retina were assessed using OCT and fundus imaging.23,49,54
The most commonly reported side effect is an afterimage; however, this is generally short-lasting, disappearing within several minutes. A study including 139 children found only two reported a laser afterimage duration exceeding six minutes on initial assessment and were therefore excluded from the study as they were deemed too sensitive to the visual stimulus.54
“IT IS NOW WELL ESTABLISHED THAT SPENDING MORE TIME OUTDOORS DURING CHILDHOOD LOWERS THE RISK OF DEVELOPING MYOPIA, AND MAY EVEN DELAY MYOPIA PROGRESSION”
examined laser pens available to the public online and on the high street, finding that many of these laser toys were incorrectly labelled and more powerful than their label described, with a significant proportion shown to be Class 3B or Class 4 lasers.53 To put this into context, these laser pen toys were shown to emit more than 1500 times greater power (up to 500mW) than the Class 1 laser used in RLRL therapy and biometry devices, hence they are not suitable for use by consumers and may pose a risk of eye injury.
Among the RCTs available, the incidence of adverse events
A meta-analysis of eight studies including approximately 1000 children found no reports of serious adverse events such as glare, flash blindness or lasting afterimages, and observed no structural damage to the photosensory layer of the retina with OCT imaging.41 Likewise, four separate RCTs reported that vision remained stable in over 400 children treated with RLRL therapy for up to one year, and there were no significant differences in BCVA observed between treatment and control groups after the treatment period.23,49,54,55
A concerning case study published in JAMAin May 2023 reported a
12-year-old who suffered two weeks of bilateral vision loss of two lines (drop in BCVA from 6/6 to 6/10) after five months of RLRL treatment for moderate myopia.56 Baseline fundus photos and OCT images were normal; however, post-treatment images revealed bilaterally darkened foveae and hypo-autofluorescence of the maculae, as well as disruption in the foveal ellipsoid zone and interdigitation zone of the retina. Electroretinogram (ERG) also showed a decreased response at the macula. After three months of ceasing treatment, the retinal damage partially recovered and bilateral BCVA improved to 6/7.5. The authors suggested that some children may be more sensitive to retinal phototoxicity that others. This particular child was noted to have an afterimage lasting up to eight to 10 minutes; hence it is hypothesised that this adverse event may be prevented in the future by ceasing treatment in children with long afterimages.
In addition, Eyerising International emphasises that its RLRL therapy device cannot be used in conjunction with atropine treatment. This combination of treatments is prohibited due to the potential risk of laser overexposure caused by the atropine’s dilating effects on pupil size. However, it is well known that children’s pupil size can vary significantly,57 therefore it may be speculated that children with naturally larger pupils may be exposed to more than the recommended power of light with this therapy. Hence, further work to assess pupil size under the conditions of the RLRL therapy is warranted.
More recently, a paper published in January 2024 has highlighted that the output from some RLRL devices could put the retina at risk of photochemical and thermal damage, underlining the need for caution when using this therapy in clinical practice.58
Given the conclusions of this work, practitioners should ensure regular follow-up of children undergoing this treatment and adopt a low tolerance for risk.
Guidance from the Association of Optometrists (AOP) currently states that practitioners offering RLRL therapy should ensure they keep their knowledge up to date in this evolving area of clinical practice and remain vigilant for unexpected findings. It is recommended that practitioners establish baseline measures of retinal function prior to treatment, such as visual acuity, monocular colour vision, enface fundus images and OCT scans, and repeat these regularly to enable comparisons to be made throughout the treatment period.59
As the evidence base for RLRL therapy for myopia management continues to develop, practitioners should remain alert to guidance updates from professional bodies on its use in clinical practice.
To date, studies have investigated the effects of RLRL therapy on the development and progression of childhood myopia over relatively short time periods of two years or less.
Further trials over longer periods are needed to better understand the long-term efficacy and safety of accumulative exposure to RLRL therapy for myopia management. In addition, it would be beneficial for future work to explore the optimal treatment regime, including the most appropriate combination of wavelength, power, duration and frequency that will give the treatment effect with the least risk of adverse events. Likewise, the rebound phenomenon should be addressed, and whether tapering of treatment can mitigate these effects or if treatment should be continued beyond a critical age for more stable results after cessation.
The studies available have used OCT and fundus imaging to screen for structural changes to the retina over the course of RLRL treatment; however, adverse effects caused by this therapy may require more sensitive tests of visual function to detect early signs of therapy induced damage. So far, the only functional measure used has been visual acuity; however, we know that visual function is much more than acuity alone, it comprises many factors including contrast sensitivity, visual field, colour vision and light-dark adaption. Future work should aim to evaluate other aspects of visual function that may be impacted by this treatment.
In addition, studies to date have all been conducted in China which limits the translation of these results to other ethnic groups and geographic locations. There are currently multiethnic trials underway in Australia and the US, which will help to address the efficacy and safety of this novel therapy among other populations.
Cost benefit studies should explore whether one device may be used for multiple children, for example, one device used for multiple children in a household, or devices used in schools to treat children on a larger scale in countries with a high prevalence of myopia.
To read this article online, access the references and take the exam, visit: www.optometry.co.uk/cpd

Dr Rebecca Leighton is an optometrist and postdoctoral researcher within the Optometry and Vision Science Research Group at Ulster University.

This article describes the genetics and common clinical features of retinitis pigmentosa and Usher syndrome.
Dr Alexis Ceecee Britten-Jones BOptom(Hons), PhD and Sena Ayse Gocuk BSci (Hons), DOptom, MPhil
Inherited retinal diseases (IRDs) are rare eye conditions caused by genetic variants that typically result in a progressive loss of photoreceptors or their ability to function. Until recently, all IRDs were untreatable. The world’s first gene therapy for an eye disease, Luxturna (Voretigene neparvovec-rzyl, Spark Therapeutics, distributed by Novartis in the UK), was approved in 2017 for IRDs caused by genetic variants in the RPE65gene.
As primary eye care providers, optometrists are often patients’ first point of contact in the healthcare system and play an essential role in identifying those with IRDs in the community,
initiating diagnosis, coordinating co-management, and providing long-term care.
This article aims to provide practitioners with an overview of retinitis pigmentosa (RP), the most common IRD phenotype. We will discuss the clinical diagnosis of RP, disease subtypes, ocular and genetic associations and emerging treatments to assist optometrists in managing patients with RP and other IRDs and provide an update for dispensing opticians to consolidate their knowledge in the subject area.
RP is not a single disease entity, but rather a group of IRDs that cause progressive photoreceptor loss. RP is a form of rod-cone dystrophy, whereby rod photoreceptors are affected earliest in the disease process. RP affects approximately one in 4000 individuals.1

Around 70 genes have been associated with non-syndromic RP and 80 genes have been associated with syndromic IRDs.2 RP disease severity and progression varies systematically between different genetic subtypes. RP inheritance patterns and their disease associations are discussed in detail in a later section.
Symptoms of RP typically present from the second decade of life, but the age of onset can range from childhood to the sixth decade. Most affected individuals are symptomatic by 30 years of age.3
Symptoms of RP may include:
• Nyctalopia (poor night vision)
• Poor adaptation to light or dark conditions
• Reduced peripheral vision
• Photophobia and glare sensitivity
• Difficulty with depth perception
• Poor colour perception
• Progressive vision loss leading to deterioration of central vison later in the disease process.
Clinical examination findings relevant to RP include refraction and best corrected visual acuity (VA) (to manage associated refractive error), pupil responses (particularly for early-onset disease), anterior segment examination (to assess for cataracts), intraocular pressures, visual field assessment and retinal fundus examination to detect early signs of RP.
Multimodal imaging, including optical coherence tomography (OCT) and fundus autofluorescence, can provide additional information on photoreceptor integrity and identify coexisting ocular comorbidities.
Fundoscopy signs of RP include (see Figure 1):
• Bone-spicule like pigmentation, generally starting in the mid-peripheral retina, and often bilateral
• Attenuation of retinal arterioles
• Waxy pallor of the optic disc. Patients with RP often have other ocular comorbidities, including:4
• Cystoid macular oedema (CMO) (approximately 50% of cases)
• Posterior subcapsular cataracts (20% of cases)
• Epiretinal membrane (ERM) (20% of cases).
Fundus autofluorescence imaging is useful for assessing the extent of photoreceptor loss and monitoring disease progression in RP.
An increase in fundus autofluorescence (hyperfluorescence) in RP show areas where the retinal pigment epithelium (RPE) and overlying photoreceptors are metabolically distressed or degenerating. Decreased fundus autofluorescence (hypofluorescence) show areas where RPE or photoreceptors are atrophic (see Figure 2, page 62).
The area between the relatively normal central retina and peripheral atrophy is also known as the transition zone. This zone corresponds to the area on OCT where the ellipsoid zone terminates, and there is progressive structural thinning of the outer retinal layers outside of the transition zone.
Combined with clinical assessment, electrophysiology is useful for diagnosing RP and differentiating early-stage RP from choroideremia and other photoreceptor diseases. In RP, electroretinogram (ERG) abnormalities often occur early and may precede the characteristic fundoscopic signs.3 RP manifests as abnormalities of the photoreceptor-mediated parts of the ERG and may present with a reduced or absent photoreceptor response (a-wave) and prolonged implicit time (with secondary reductions in bipolar b-wave signal). Specifically, rod function is reduced in the early stages with cone dysfunction occuring later in the disease course.5,6
The inheritance of disease affects how the disease-causing gene is inherited and transmission of phenotypes within families.7 RP generally follows patterns of autosomal recessive (50-60%), autosomal dominant (30-40%) and
X-linked (~5-15%) inheritance.8,9 Rarely, RP can also be passed down through maternal mitochondrial DNA or digenic inheritance (<1%).10,11
When a variant in one allele is sufficient to result in a genetic disease, it is an autosomal dominant condition;7 this means the trait appears in multiple generations with a 50% risk of inheritance from an affected parent and both females and males are affected equally.7,8 The most prevalent genes for autosomal dominant RP are RHO(30%), PRPF31(17%) and RP1(8%).12 In terms of disease severity, autosomal dominant cases are generally the least severe and are associated with later onset of symptoms.
For an autosomal recessive inheritance pattern, both alleles must carry a pathogenic variant, that is to say, a copy of the mutated gene is inherited from each parent;7,8 this means the trait will not present in every generation of an affected family unless there is a history of consanguinity resulting in a ‘pseudodominant’ inheritance pattern. Both females and males are affected equally.7,8 The most prevalent autosomal recessive genes causing RP are USH2A(19%), CRB1 (8%) and ABCA4(8%).12
X-linked inheritance has variable expression depending on whether males or females are affected.7 Males have only one X-chromosome, so a single pathogenic gene mutation on the X-chromosome is sufficient to manifest disease. Females have two X-chromosomes, therefore, female carriers with a single pathogenic gene mutation on one X-chromosome may not always exhibit the IRD retinal phenotype. RPGR(70–80%) and RP2(10–20%) are the most common genes affected in X-linked RP.13
Until recently, a common misconception about female carriers was that they would always remain relatively asymptomatic. In fact, there are several reported cases of females with X-linked RP who were mistaken for autosomal dominant inheritance due to their severe retinal phenotypes.14 It is now understood that females who carry one mutated gene, that is to say, carriers of X-linked disease, may exhibit a variable disease phenotype, even including severe
Optometrists:
Optometrists will be able to elicit relevant history and symptoms from patients presenting with retinitis pigmentosa and explain the implications of clinical findings
Optometrists will recognise the clinical characteristics of retinitis pigmentosa and be able to manage the patient accordingly.
Dispensing opticians:
Dispensing opticians will be able to explain the key characteristics of retinitis pigmentosa to patients Dispensing opticians will consolidate their knowledge on the key characteristics of retinitis pigmentosa and recognise the clinical implications. 0 0
vision loss and phenotypes more typical of a male. An affected male with an X-linked IRD cannot pass their diseasecausing gene to their sons, therefore, there is no male-to-male transmission –a defining feature of X-linked pedigrees – however, all of his daughters will be carriers.8 Moreover, female carriers have a 50% risk of having an affected son or carrier daughter.
Despite being the least common form of RP, X-linked RP is considered to be a more severe form as defined by visual impairment, rate of
progressive degeneration and extent of retinal phenotype.15 Males with X-linked RP present with night blindness and restricted visual fields in the first or second decade of life, which often leads to complete blindness in the fourth or fifth decade.16 Female carriers of X-linked RP may present with varying clinical characteristics ranging from near normal retinae to severe vision loss, the latter known as ‘male-pattern’ degeneration (see Figure 3).17
The hallmark clinical sign of mild disease in female carriers of X-linked RP is the tapetal-like reflex, which is an ‘unusual, golden, bright scintillating, particulate reflection’ of the retina with relative sparing of the fovea (see Figure 4, page 64).18,19 This key sign may be missed with traditional colour retinal fundus photography, therefore, multimodal imaging is recommended in potential carriers to detect subtle retinal changes.
Carriers of X-linked disease may identify with a sense of shock and grief, concern about having children, a prolonged sense of guilt and anxiety about their son(s).20 Female carriers mostly learn of their carrier status after giving birth to a son with an X-linked condition.21 Early detection of the carrier status allows for referral to genetic counselling services for family planning advice. Female carriers have indicated their preference for invitrofertilisation with preimplantation genetic testing, if they had known about the possibility of having an affected child.21 There is a need to provide appropriate guidance and
support to female carriers to cope with the emotional strain of the condition and the ability to make informed decisions about family planning and potential participation in therapeutic clinical trials. Therefore, thorough history taking may reveal women at risk of having a disease-causing genetic mutation. Further investigation through multimodal imaging, particularly fundus autofluorescence, may expose subtle retinal changes, warranting referral to genetics clinic for genetic testing services and counselling.
Sector RP is a form of the condition where clinical signs are only shown in one or two fundus quadrants, commonly inferiorly and nasally (see Figure 5, page 64).
The disease is often bilateral and relatively symmetrical; however, cases of unilateral and asymmetrical involvement have also been reported.22
Compared to typical RP, people with the sectorial type often have slower disease progression and milder vision loss, with the area of visual field defects corresponding to the affected retinal quadrants.
Several different genes have been associated with sector RP, including RHO,USH1C,CDH23,PRPS1,MYO7A, EYS,IMPDH1and RP1
Light exposure has been proposed to play a role in sector RP, as most cases affect the inferior retinal quadrants. However, the molecular mechanism
underlying sector RP is unclear. Nevertheless, it is reasonable to advise patients with sector RP to use sun protection and minimise exposure to sunlight.22
When RP manifests in conjunction with systemic disease, it is termed ‘syndromic,’ affecting approximately 20–30% of people with RP. Individuals exhibiting retinal signs suggestive of RP should be investigated for any other non-ocular conditions including hearing loss, issues with balance, physical malformations, developmental impairment and kidney disease.23 The most common form of syndromic RP is Usher syndrome.
Usher syndrome is an autosomal recessive disease characterised by sensorineural hearing impairment, vision loss due to RP and vestibular dysfunction.24 Usher syndrome accounts for more than half of individuals with combined hearing and vision loss, 18% of RP cases and 10% of congenital deafness.25 Estimated worldwide prevalence is between four and 17 per 100,000 people. There are three subtypes of Usher syndrome based on onset and severity of sensorineural hearing loss and RP, and the presence of vestibular dysfunction.
Type 1 Usher syndrome (USH1) is the most severe subtype with affected individuals presenting with profound bilateral hearing loss, vision loss and vestibular areflexia.26 Worldwide, USH1
accounts for approximately 25–44% cases, type 2 Usher syndrome (USH2) for 56–75%, and type 3 Usher syndrome (USH 3) for 2% of the total cases.27
Relatively recently, an atypical Usher syndrome (USH4) has been described, which is characterised by late-onset RP and progressive sensorineural hearing loss, without vestibular involvement.28
There are currently no approved therapeutic treatments to reverse sensory impairment or stop progression in individuals with Usher syndrome. Multidisciplinary clinicians including audiologists, speech therapists, ophthalmologists, occupational therapists and genetic counsellors are required to co-manage individuals with the condition. Genetic counselling is recommended for affected individuals to understand inheritance and receive family planning advice.
Patients with RP often need ongoing optometric care for updating visual correction (for example, for high myopia), referral for visual aids and support, and monitoring for the development of other ocular comorbidities, such as posterior subcapsular cataracts, ERMs and macular holes. These can easily be missed during clinical examination because affected patients might not report new symptoms and ocular changes are assumed to be related to their IRD.
Many patients with late-stage IRDs report visual hallucinations caused by the brain’s adjustment to significant vision loss, a phenomenon known as Charles Bonnet syndrome (CBS). The visual hallucinations can be of simple patterns (such as shapes of lines) or sophisticated figures (such as people or animals); be moving or still; happen suddenly or last several minutes or hours. There is currently no cure for CBS. However, it is important that patients know that the hallucinations are not real and have coping strategies for when they occur (for example, some people may find it helpful to move to a lighter or darker room, or to move their eyes around). Several organisations, including the Royal National Institute of Blind People and the Macular Society, have resources to help patients understand CBS.
Lifestyle modifications that can be recommended to patients to improve retinal health include limiting UV exposure (for example, sunglasses that filter UVA and UVB light) and smoking cessation.29 General dietary recommendation for maintaining eye health is eating a well-balanced diet high in antioxidants, vitamins and other nutrients,30 including:
• Dark, green leafy vegetables, such as spinach or kale, and fresh fruit daily
• Oily fish twice a week
• A handful of nuts a week.
There is much controversy surrounding the impact of vitamin A on RP disease progression. A recent study suggests that its effects for individual patients may depend on the mechanism of the causative gene.6 For example, vitamin A supplementation has been reported to have negative effects in people with USH2A-and EYS-related RP but a beneficial effect in RHO-related RP.6 Nonetheless, there is inconclusive evidence regarding the role of vitamin A in slowing the progression of RP and high-dose vitamin E (>30 IU/day) should be avoided.
Other oral antioxidant supplementations are also being evaluated for RP, including N-acetyl cysteine (NAC) supplementation,31 and other antioxidants.32
Of note, Refsum disease is a specific type of syndromic RP that is affected by nutrition.33 Refsum disease is a metabolic disorder characterised by the build-up of phytanic acid in blood plasma and tissue, and also causes loss of smell/taste, progressive deafness, peripheral nerve loss with raised cerebrospinal fluid (CSF), proteinuria and ataxia. Management for Refsum disease includes strictly adhering to a diet that excludes or is low in phytanic acid. Phytanic acid is in dairy products, beef and lamb, and fatty fish such as salmon, mackerel, sardines, and cod.
Having genetic testing helps provide a more accurate diagnosis and will allow patients to make informed




family planning decisions. A confirmed molecular diagnosis is also required to ascertain patients’ eligibility for gene therapy clinical trials and treatments. Using current genetic sequencing technology, the genetic fault that is causing RP can be identified around 50–70% of the time.34
Genetic testing involves close consultation with a multidisciplinary team, often involving ophthalmologists, clinical geneticists, genetic pathologists, molecular scientists and genetic counsellors. There are also several UK genomic laboratory hubs that can perform IRD genetic testing, and national and international initiatives to characterise the genetic basis of IRDs, such as the 100,000 Genomes Project and UK Biobank.35 Many ophthalmic units now also have dedicated genetics clinics where they can offer genetic testing embedded within appropriate clinical assessment/monitoring, genetic counselling support and access to research programs.

Nonetheless, it is also important for optometrists to keep their knowledge up to date on both ocular genetics (for example, implications of genetic testing for different eye diseases and emerging therapies) and foundational genetics (for example, types of genetic

tests and inheritance patterns) to improve patient access to care.36 Many patients also want increased levels of ongoing genetic support from local providers.37
Gene-specific therapies are being developed for several IRDs,38,39 including RPGR-related X-linked RP, PDE6A-related RP, and RHO-related RP. Gene therapy treatment primarily aims to prevent disease progression and not to reverse vision loss.35
Many gene-independent neuroprotective agents are also being evaluated in clinical trials, as well as RNA and stem-cell treatments generally targeting mild and moderate disease stages, and optogenetics for end-stage disease in which there are no rods or cones. With emerging therapies for different stages of IRDs,
optometrists can discuss research participation with their patients and refer them to specialist centres where relevant. Patients can then be provided with information on available studies to make an informed decision about whether they would like to be involved in research programs and clinical trials.
RP encompasses a diverse group of genetically and clinically heterogenous disorders. Primary healthcare practitioners hold a pivotal role in recognising early symptoms of RP, managing ocular comorbidities, identifying syndromic associations, and facilitating referrals to tertiary services and research programs, including clinical trials. Clinicians’ proactive management of individuals with RP can significantly contribute to the advancement of research and the development of future treatments for these conditions.
To read this article online, access the references and take the exam, visit: www.optometry.co.uk/cpd

Dr Alexis ‘Ceecee’ Britten-Jones is a postdoctoral research fellow and optometrist in Melbourne, Australia.


Sena Ayse Gocuk is an optometrist and PhD candidate at the University of Melbourne investigating female carriers of X-linked inherited retinal diseases.

1. Fleckenstein Met al. Ophthalmology. 2018;125(3):369-390.

This article will consider simple interventions to manage dry eye disease and improve patient wellbeing.
Sheena Tanna-Shah BSc (Hons)Looking after health and wellbeing should be a top priority in order to lead happy and fulfilling lives. The world is experienced through our senses and research has shown that sight is the most valued sense.1 Yet, what proportion of the population are in the habit of having regular examinations to ensure they prioritise their ocular health? According to research by Théa in 2021, 38% of those surveyed had not been for an eye examination within the past two years citing reasons such as the financial cost, fear of the examination and equipment, or not feeling the need to visit as did not have any specific concerns.2
One of the issues people struggle with more than ever is dry eye disease (DED), a condition which can have a detrimental impact on daily life when it is not managed effectively. Data released by Théa reported that one in four people are thought to suffer with DED.3 Many things can contribute towards this, including increased time spent on screens and digital devices, especially since the COVID-19 pandemic.
The Tear Film and Ocular Surface Society (TFOS) is a global organisation dedicated to advancing
the understanding and management of DED. In 2017, TFOS published an update to their 2007 International Dry Eye Workshop (DEWS) report. The DEWS II report provided a revised, comprehensive definition of the condition: ‘Dry eye is a multifactorial disease of the ocular surface characterised by a loss of homeostasis of the tear film, and accompanied by ocular symptoms, in which tear film instability and hyperosmolarity, ocular surface inflammation and damage, and neurosensory abnormalities play etiological roles.’4
Broadly speaking, there are two types of DED: aqueous-deficient; and evaporative. Aqueous-deficient dry eye (ADDE) occurs when the lacrimal glands, which produce the watery component of tears, do not produce enough tears to keep the eyes lubricated; this can be caused by a variety of factors, including ageing, hormonal changes, systemic conditions, such as Sjögren’s syndrome and certain medications, such as antihistamines and diuretics. Evaporative dry eye (EDE) occurs when the meibomian glands do not produce enough oil or the secretions are of poor quality; this can lead to an unstable tear film and increased evaporation of tears from the ocular surface.
DED can cause a range of signs and symptoms, including dryness, watering, itching, burning, redness, grittiness and blurred vision. These symptoms may be intermittent or persistent and can vary in severity. In severe cases, DED can lead to corneal damage and result in vision loss.4
Factors such as ageing, contact lens use, exposure to wind and dry air, other environmental issues, alcohol consumption, lack of certain vitamins and prolonged use of digital devices can all contribute to the development of DED.4
Tear production decreases with advancing age and this can lead to a higher risk of dry eye. Women are also more likely to develop dry eye than men, particularly after the menopause, due to hormonal changes.4
It is important when taking history and symptoms to recognise specific conditions and medicines which can cause or exacerbate DED. Conditions such as rheumatoid arthritis, Sjögren’s syndrome and diabetes can increase the risk of dry eye.5 Certain medications, such as antihistamines, decongestants and antidepressants, can reduce tear production, leading to signs and symptoms of dry eye.6
One particular area to consider is whether DED causes low mood and depression or vice versa. Several classes of antidepressants have been reported to cause or worsen DED.7
“ONE OF THE ISSUES PEOPLE STRUGGLE WITH MORE THAN EVER IS DRY EYE DISEASE, A CONDITION WHICH CAN HAVE A DETRIMENTAL IMPACT ON DAILY LIFE WHEN IT IS NOT MANAGED EFFECTIVELY ”
Tricyclic antidepressants (TCAs) are a class of antidepressants that work by increasing the levels of certain neurotransmitters in the brain. TCAs such as amitriptyline, doxepin and imipramine have all been associated with dry eye symptoms. Selective serotonin reuptake inhibitors (SSRIs) are another class of antidepressants that work by increasing the levels of serotonin in the brain. SSRIs such as fluoxetine, paroxetine, citalopram and sertraline have been reported to cause or worsen dry eye symptoms. A study published in 2017 evaluated the effects of SSRIs on dry eye symptoms.7 The study found that patients taking SSRIs had significantly higher dry eye symptom scores compared to a control group. Among the specific SSRIs studied, sertraline was found to have the strongest association with dry eye symptoms. While the exact mechanism is not fully understood, it is thought to be related to their effects on the autonomic nervous system and tear production. If a patient is taking an SSRI and experiencing dry eye symptoms, their general practitioner (GP) may be able to discuss alternative approaches.
Serotonin and norepinephrine reuptake inhibitors (SNRIs) are a newer class of antidepressants that work by increasing the levels of both serotonin and norepinephrine in the brain. SNRIs such as venlafaxine and duloxetine have also been associated with dry eye symptoms.8
DED can impact mental and physical health in many ways with one study reporting that the condition can reduce visual function, limit the ability to do certain activities and impair work productivity.9 The same study found that 47% of patients with DED reported anxiety or depression compared to 32% without the condition. These findings highlight that if DED is not effectively identified and managed, it can negatively impact daily life in a variety of ways, including overall wellbeing. Raising awareness of DED is key in order to prompt individuals to seek
professional guidance so that tailored management steps can be introduced.
The menopause can also have a significant impact on the development and severity of DED in women. During the menopause, the body experiences a decline in the production of androgens, including oestrogen, which is a hormone that plays a key role in maintaining the health and function of the ocular surface. Oestrogen has several effects on the ocular surface, including stimulating the production of tear film components and maintaining the integrity of the corneal epithelium. As oestrogen levels decline during the menopause, these effects are diminished, which can lead to a decrease in tear production and an increase in ocular surface inflammation. When the androgen hormone decreases, this affects the meibomian and lacrimal glands in the eyelid causing inflammation and reduced tear production.10 The prevalence of dry eye symptoms was cited as 52% in a group of 200 postmenopausal women with the severity of symptoms significantly associated with the duration of menopause.11 A large-scale study found that women who used hormone therapy for birth control, infertility or menopausal symptoms were more likely to report dry eye.12 More research needs to be done to determine whether taking hormone replacement therapy (HRT) to support menopause causes further dry eye issues or helps reduce it. One study showed that women who use HRT, particularly oestrogen alone, are at increased risk of having DED.13
There are many factors associated with DED that patients may not be aware of, and therefore, do not know what adjustments and treatments are available to help and support them; this can significantly impact their day-to-day life in many ways resulting in them feeling low, anxious and can lead to depression.
LEARNING OUTCOMES
Optometrists and Contact lens opticians: Optometrists and contact lens opticians will be able to elicit relevant history and symptoms from patients presenting with dry eye disease
Optometrists and contact lens opticians will recognise systemic conditions and medications that can cause or exacerbate dry eye disease.
Dispensing opticians: Dispensing opticians will recognise the aspects of patient history and symptoms that are relevant to dry eye disease
Dispensing opticians will recognise systemic conditions and medications that can cause or exacerbate dry eye disease.
If DED is impacting a patient’s working day then this can lead to feelings of negativity, lack of motivation and reduced productivity. If the patient’s occupation involves using screens it may become harder to focus, their eyes may feel tired or sore, making it difficult to fulfil work commitments; this may result in missing work deadlines or even
having to take time off sick. If the patient enjoys particular hobbies that lead to a worsening of dry eye symptoms, it may lead them to stop these activities which could impact upon their general wellbeing. For example, they may enjoy walking and running but having to put up with watery eyes might make the experience uncomfortable and difficult to tolerate. Giving up these activities may affect both mental and physical wellbeing. DED can impact upon other important tasks such as driving, which may result in loss of confidence and even social isolation. The potential loss of freedoms that the patient would otherwise enjoy can lead to a deterioration in their mental health; this may result in the need to take anti-depressants which in turn could exacerbate their DED.8 Furthermore, DED can cause the patient’s eyes to look red and puffy which can affect their confidence if they are conscious about their image.
When a patient comes in with possible dry eye symptoms it is essential to take a detailed history to understand their day-to-day life and see if there are potential factors that may be contributing towards their condition. If they use a screen for a significant proportion of the day, it is important to ascertain how many hours they are using it for, if they take regular screen breaks, are they working from home, in an office, or mixture. Check environmental factors such as heating or air conditioning. Are the symptoms at a particular time of day, related to being in a specific environment or when undertaking particular tasks?
It is helpful to explain to patients with DED why information about their lifestyle and habits is required so they can better understand the relevance of any follow up questions, for instance, how much water they typically drink, the amount of alcohol they consume, or if they are currently going through the menopause.
Asking these questions may feel invasive to the patient, but by using a considered approach, and explaining

the reasoning beforehand, will usually make them responsive. This is also a good time to revisit medications as some patients may not always feel comfortable stating they are on anti-depressants or appreciate the relevance in the context of dry eye.
There are several, simple practical steps that can be introduced to help support patients with dry eye symptoms depending upon the subtype and severity of their condition:
• Artificial tears are readily available and can be used as often as required. Reinforce the importance of using preservative-free drops where possible to avoid the potential for an allergic response
• Warm compresses to improve meibomian gland function
• Blinking exercises
• Taking regular breaks from screen use
• Use a humidifier and limit the use of heating and air conditioning where possible
• Maintain good eye hygiene
• Stay hydrated
• Reduce alcohol consumption
• Consider dietary changes: some research suggests that certain nutrients,14 such as omega-3 fatty acids, may help support eye health
and reduce dry eye symptoms. Omega-3 fatty acids, found in fatty fish such as salmon, tuna, and sardines, have anti-inflammatory properties that may help reduce dry eye symptoms. Vegetarians can get omega-3 from nuts and seeds, such as flaxseed and walnuts.
Practitioners play a vital role in identifying patients presenting with DED. Successful management can result in resolution of symptoms and a wider impact on the patient’s wellbeing. It is helpful to follow up these patients to ensure that any advice is being adhered to and is helping to resolve their symptoms or to identify if further intervention is required.
To read this article online, access the references and take the exam, visit: www.optometry.co.uk/cpd







This issue’s must reads...

LATEST LAUNCHES
An ocean-inspired collection and new tools for myopia management
To feature in OT’s What’s happening pages, contact: kimberleyyoung@optometry.co.uk
GEN S LENS LAUNCHED AT TRANSITIONS ACADEMY -
The lens is ultra-responsive to light and will utilise HD vision and a new colour palette to revolutionise the lens category, Transitions said www.optometry.co.uk/gens

Etnia Barcelona has launched the Underwater campaign for its spring/summer 2024 collection, evoking the mystery of the deep sea.The collection includes 22 new models, 18 for prescription and four sunglasses, including the ‘Posidonia’ (pictured). etniabarcelona.com



SOFTWARE
Ocumetrahasaddednew featurestoitsmEYEGuide andmEYEGaugeformyopia management.Thisincludes atoolforaxiallength analysisusingestimatedor measureddata,alongwith axiallengthtreatment targetstofacilitate improvedcommunication. ocumetra.com
SPECTACLES
Caron Eyewear has released new models, celebrating “bold femininity,” comfort and wearability.The striking statement piece, ‘Fit to win,’ is a shallow, angular square shape and available in the colours: electric blue, black, fluorescent pink, or crystal rose. caroneyewear.com


INSTRUMENTS
100% Optical saw the launch of the Zeiss Atlas 500 multi-modality ocular surface analysis device in the UK.The solution facilitates corneal topography, pupillometry, and dry eye assessment from one device with high resolution output. zeiss.co.uk
SUNGLASSES
SwissEyewearGrouphas partneredwithmaterials company,Eastman,onthe launchofanewcollection celebratingthe10th anniversaryofInvu Eyewear.Framesinthe anniversarycollectionare formedfromEastman TritanRenew–amaterial madewith50%certified recycledcontentderived fromhard-to-recyclewaste. invueyewear.com





The Body Doctor has launched the Dry Eye Revolution initiative to support practices to establish a dry eye clinic in 30 days, partnering with Advanced Ophthalmic Services to offer a free three-month trial subscription to AOS software. the-body-doctor.com

Eyes are the story took to the stage at 100% Optical as the make-up worn by models in the event’s legendary catwalk show.The brand was also part of Positive Impact’s stand in the exhibition. positiveimpact.co.uk







Grafton Optical has highlighted the MeiboVue Smartphone Meibographer, a portable device to aid the diagnosis and monitoring of dry eye disease and meibomian gland dysfunction. graftonoptical.com
EssilorLuxottica is running bundle promotions for dry eye equipment, enabling practices to purchase the IDRA diagnostic device or theTearStim IRPLdevice and receive 50% off an Activa heat and massage mask. If purchasing both devices, they can gain the Activa free. ecp.essilor-pro.com
Aston Vision Sciences showcased its new high fidelity fluorescein filter at 100% Optical with a specially calibrated colour formula.The filter can be handheld or used on compatible slit lamps. astonvisionsciences.com


Scope has highlighted the Hycosan Intense eye drops as a “next step” in therapeutic lubrication for patients experiencing intense dry eye symptoms such as burning, itching, and tearing.The formula contains a blend of high molecular weight Hyaluronic Acid and Ectoin and acts like a gel. scopeeyecare.com
clariti' 1 day

Health;comfort andgreat valuet 1 - all in one.
Health* - One-day lenses are the healthiest way to wear soft contact lenses. With silicone hydrogel material for high breathability and UV blocking.. for added protection.
Comfort - Optimised Comfort Edge'"and Wetloc'" Technology for all-day wearer comfort and hydration. Valuet 1 - Available across sphere, toric and multifocal at a great price.t
Recommendclariti®1 day today. coopervision.co.uk
* With high oxygen delivery for daily wear, SlH materials minimiseor eliminate hypoxia-related complication.
** Warning:UV-absorbingcontact lensesare not substitutesfor protective UV-absorbingeyewear,suchas UV-absorbinggogglesor
Co-founder of the eyewear blog, LaEspejuelos, on a love for independent brands



Spectacle wearer from: a young child
Years in profession: more than 20
As an opticianoptometrist, being the primary agent of visual health is the basis of everything. A premium optometry service is usually associated with a distinctive optical service offering independent collections and cutting-edge personalised optical solutions.


I have been an optician-optometrist for more than 20 years. I completed my diploma studies in optics-optometry at the University of Santiago de Compostela as well as a Master’s in advanced clinical optometry. A while later, the optics and optometry degree was created and so I returned to university for another year of study, as well as another year of Master’s degree in clinical optometry and research. In total, it is now a four-year degree in Spain with a minimum of one year of specialisation.
My go-to styles include oversized rectangular shapes. Or even round shapes combined with bright colours. I like styles with double bridges.
READ MORE
La Espejuelos co-founder, Nuria Gómez, shares her eyewear style on OT: www.optometry.co.uk/ ot/me-and -my-glasses
My mother is an optician-optometrist like me. She has had an optometry office in her independent opticians since 1972. Since I was little I have had regular check-ups. I have had a slight astigmatic correction since I was a little boy.
My background in optics is clearly inherited. My family has an optical shop in our hometown of Ourense, Spain, and I worked in the business for 10 years. I developed a great passion for independent designs.
For a few years 100% Optical has been focusing on attracting new exhibitors and alternative creators who bring something new to the UK market. Little by little, a new independent movement is being created thanks to professionals looking for something different to offer their patients.

Kirk & Kirk has launched the world’s first handmade acrylic sunglass collection. It has taken the family business five years to develop the unique material for its signature bold, chunky designs. kirkandkirk.com

Eyespace has launched a new brand, Arhlo, focused on inclusivity and a respect for the environment. The frame, ‘ARH001,’ is a stand-out from the new collection. eyespace-eyewear.co.uk



Optometrist and lifestyle blogger, Lizzy Yeowart, on the resurgence of a stand-out style. See more from Lizzy on her Instagram page at @WHATLIZZYLOVES

The cat’s eye, ‘Carolina’ by JF Rey, was inspired by the style of Lady Gaga, featuring contrasting shapes and thicknesses with artful bevelling to give a multi-faceted appearance. maceyewear.co.uk

‘OA2115C2’
Outspoken’s eyewear collection has always celebrated the quirky and unusual. In an array of colourways, its asymmetrical style is an attainable option to embrace the trend.
outspokenholland.com






Asymmetrical eyewear is not a new concept. However, the design is currently at the forefront of eyewear fashion courtesy of an array of new styles.
Dolce & Gabbana’s ‘Half print’ sunglasses have a different pattern detail on each side in a more subtle nod to the asymmetric trend. The frames are inspired by the brand’s Sicilian DNA. dolcegabbana.com

‘Wonk’
The box-office hit Wonka has brought attention to asymmetric frames thanks to ‘Wonk,’ Tom Davies’ crystal blue design which is part of his latest collaboration with Warner Bros. catchlondon.net

FLEXIBLE·SAFE·COMFORTABLE·HIGHLYADJUSTABLE multi-award-winningRidseyewear BABY TO ADULT SIZES

Fullyadjustable Ultra lightweight Flexible Non-slip Comfortable Durable Headstrap Non-toxic
Founder and CEO, Professor David Thomson, on developments in technology and giving back

What makes the company unique?
Thomson Software Solutions evolved out of research I was doing at City, University of London and we do still try and adopt an evidence-based approach to everything we do. For a small company, we have an impressive record for innovation, developing the first computerisedTest Chart, first Near Vision App, first Clinical EyeTracker, and first computerised Hess Screen.
What is the latest solution that you have released and why does it stand out?
At 100% Optical, the updated version of the Thomson Near Chart and new Virtual Synoptophore seemed to draw the crowds. A few years ago, we saw the development of phones and tablets with very high-resolution screens which made them ideal for presenting visual stimuli. We developed a near vision testing app, and theThomson Near Chart takes this a stage further, linking a PC to any phone or tablet using a QR code. The practitioner can then control what is


displayed on the device directly from the PC. The Virtual Synoptophore uses the same approach to present pairs of images on a phone, which is inserted into a virtual reality headset, providing a huge range of binocular vision tests.
What are the company’s main aims for the next 12 months?
We have a backlog of ideas and innovations waiting to be implemented. We have exciting new modules for the Clinical EyeTracker coming online. We aim to run more webinars and CPD this year to explain the purpose and benefit of our software for practice.
How does the company seek to support the wider community?
Recently, we have extended our support for Vision Care for Homeless People (VCHP) by providing test chart systems for all their new clinics. It is brilliant that VCHP is expanding, and we’re happy to continue providing the hardware and software for testing.
ThomsonTestChartsare usedtoassessthevisionof morethan100,000 patientseachday
Thecompanyisbased inHertfordshire
ProfessorDavidThomson alsorunsaCommunity Caféonceaweek, providingawarmspace andfoodforthepeopleof PottersBar.

Manufacturers on products designed for motorists, and how to bring the topic into consultations with patients

The topic of vision and driving made headlines this year as the RAC called on the Government to commission an independent study on the issue of glare from car headlights. With the public talking about glare, nighttime driving, and vision, it may be an appropriate time to highlight lenses and coatings designed with these needs in mind.
Experts at Seiko suggested awareness of driving lenses as a category is still growing, led by conversations between practitioners and patients.
Jonathan Cohen, commercial manager at Seiko Vision UK, said: “It is rare to have a
patient walk into practice and say, ‘I want driving lenses.’ You uncover that need through open questions and then make the best recommendation.”
The company offers both single vision and progressive lens designs specifically tailored to motorists with Seiko Drive and Seiko Drive X. The lenses are structured to provide edge-to-edge clarity supporting the peripheral vision of drivers. The progressive lenses also provide a focused area in the intermediate zone to support the view of the dashboard.
Michelle Lloyd-Bibb, professional services manager for Seiko Optical UK, recommended using lifestyle questions to delve deeper into the needs of the patient: asking not just
whether they drive, but how many hours they spend on the road, or the times of day that they tend to drive.
She said: “That gives me insight as a dispensing optician into how much of a priority a potential solution is going to be for them. Is it something that we can address with an anti-reflective coating? Does it require a solution from our drivespecific lenses?”
In addition to the driving lenses, Seiko offers the Road Clear Coat, which can provide an alternative solution for patients who perhaps do not require a separate pair of specific lenses for driving.
Bolstering further awareness amongst patients of driving lenses as a category will come from practice teams. Cohen shared: “The recommendation between the testing room and the dispensing desk is where the magic happens.”
Essilor has recently made its Crizal Drive anti-reflective coating available with Eyezen and Varilux Comfort Max lenses.
Alan Pitcher, commercial director for wholesale lenses at EssilorLuxottica, explained that the move to extend the driving range was initially prompted by feedback from practices.
“We agreed it would help allow more patients to benefit from a better clarity of vision throughout the day and maximise their night vision to feel safer on the road,” he said.
The company suggests the lenses offer up to 90% less reflection at night, at 507nm “where eye sensitivity is the highest” compared to a lens with a hard coat. This helps wearers experience a decreased sensation of glare and enhances visual comfort when driving.
Pitcher suggested that driving can form part of the lifestyle conversation of ECPs with patients: “This will help establish whether the patient struggles with glare and whether an anti-reflective coating such as Crizal Drive could be beneficial to offer greater clarity of vision on the road.”
Launched last year, Shamir Driver Intelligence features one set of lenses for day, ‘Sun,’ and another for night and lowlight conditions, ‘Moon.’
The ‘Sun’ lenses incorporate a coating to reduce glare, while the ‘Moon’ lens is designed to compensate for the myopic shift experienced at night.
Russell Bickle, general manager of Shamir UK, highlighted a survey by the manufacturer in 2016 of 59 participants that illustrated challenges experienced by drivers, particularly driving at night and in bad weather.
Bickle also pointed to a market research study of 1086 participants by Sanita Advisors in 2023, which found 48% reported visual concerns prevented them from driving at night.
As part of its investigation into the needs of drivers, Shamir formed a strategic optical performance partnership with BWT Alpine F1 in 2021, with feedback contributing to the development of Shamir’s new driving lenses.
Discussing how the topic of driving lenses can be addressed in practice, Bickle recommended asking patients whether they experience eye strain, disturbing glare, a limited field of view, and trouble adjusting between viewing zones when driving.
Reassure patients that they are not alone in their experience, he added, and highlight that drivingspecific lenses could be an option to help alleviate challenges, working through potential benefits the lenses can provide.
In October 2023, the AOP surveyed 1193 members on their views regarding the vision requirements for driving in the UK. Participants were asked to express the extent to which they agreed with a set of statements. The survey found that of the optometrists asked:
70%
strongly agreed a full vision check should be mandatory for every new driving licence
67%
strongly agreed a vision check should be mandatory every 10 years to maintain a driving licence
72%
strongly agreed a vision check should be mandatory every three years for drivers over 70 years old
The Don’tswerveasighttest campaign will return this summer. Visit the AOP website for more information and to get involved.
www.aop.org.uk/dontswerve
This February, Nikon Lenswear UK launched the SeeCoat Next Drive as part of its portfolio of advanced light management lens coating solutions.
The SeeCoat Next Drive features a Glare Reduction filter to reduce the effect of glare caused by oncoming headlights, streetlights, and other light sources in dim or dark conditions.
Nikon suggested the coating offers “superior vision in the light, providing the ideal solution for driving at any time of day or night.”
“It is rare to have a patient walk into practice and say, ‘I want driving lenses’”
Jonathan Cohen, commercial manager at Seiko Vision UK

he key thing CHEC provides is a short waiting time. A lot of the main hospitals have huge waiting lists, and easing the burden for them is important. Rather than patients worrying for months about what’s going to happen, we can provide appointments within a shorter time frame. Outpatient cataract surgery is usually within a few weeks.
Patients are often surprised. Most are resigned to accepting that it will be three or six months, or sometimes even a year. People might be waiting for hip operations, for example, and they assume the eye department will be the same. Some patients think about going private, because they assume it’s going to be much quicker. They get a welcome surprise when they realise they can still have their surgery under the NHS, still get a good level of service, and have the same waiting time as they would privately – without having to spend a lot of money.
CHEC has NHS partner executives who regularly go and see local optometrists, to let them know about what CHEC is doing, how they can communicate with us, and how they can refer their patients. They’ve got a clear point of contact.
We keep up good contact with optometrists. I used to work at a practice in Chorley, so I was already aware of CHEC before I started working
here. When a patient comes in for an appointment with CHEC, the optometrist will automatically get a letter so they can keep up to date with the care the patient is receiving.
Most referrals we get are via Opera. The referral goes through a management centre and is allocated to locations where the patient could have the procedure. It is triaged by a team of doctors, and sent to the relevant department. The triage process is very quick. I’ve had patients who have had their eye tests on Wednesday, and have come in for YAG laser on the Friday.
We can monitor referrals and make sure the patient is sent to the right clinic. Our purpose is to shorten the waiting lists. The relationship we have with optometrists means they’re aware of what we can do.
Our relationship with the NHS and with local optometry is easing the workload of secondary care. Cataract surgeries, particularly, are mainly done under topical anaesthesia, and we can provide that service here.
You’ve got people who are struggling, until they’ve had their surgery done. We can nip it in the bud, before it gets to the stage where the patient’s day-to-day activities are affected. Easing the workload makes it better for everyone.

"This a great job for optometrists to provide that clinical excellence, to make sure your patients receive the best possible care. This is the job that you signed up for when filling out your UCAS form"
Tom Critchley, Principal Optometrist, SpaMedica
Do you have a passionfor patient care and strive for clinical excellence?You could be the perfect fit for our growingteam of talented optometrists.
• Great work life balance - Only 1 in 4 Saturdays
• Continuoustraining and development
• Biannualbonuses
Lead the way with the UK's most flexible, adaptable and affordable OCT & Visual field solutions.

Visioncare Research is currently seeking eye care practitioners who fit Johnson & Johnson contact lenses to participate in a series of postmarket clinical research surveys. The purpose of these is to monitor the safety and performance of lenses in real-world use.
If you participate, you will be compensated for the time needed to prepare for and then conduct the survey. You would be asked to perform a retrospective review of your patients' records and, for each patient you review, you would be asked to complete a set of four questions regarding their experience with the lenses.
If you are interested in participating or would like more information, please contact the study team at the following email address: Research@visioncare.co.uk
OT hears how the Peer Support Line has been supporting optometrists, and about plans for a new service dedicated to pre-regs
COMMERCIAL
The Peer Support Line (PSL) is a free, confidential helpline open to all optical professionals (members and non-members) as a space for people to talk through anything that may be bothering them.
The PSL volunteers, who are all optical professionals, won’t give advice or provide the answers, but are there to listen.
In 2023, the PSL received 465 calls, a yearon-year increase of 125%. Throughout the year several common themes emerged in the types of issues identified by callers, the most common being employment issues – something raised by 26% of callers.
Of the calls received by the PSL last year, 14% were regarding stress, working conditions, and mental health, respectively, while another 10% of calls were linked to topics of family and relationships.
The calls covered issues inside and outside of the workplace, and it is good to know that callers feel they can come to the support line with whatever is bothering them. Our volunteers are there to help callers to talk any issues through.
In the past year, our volunteers noticed a significant increase in calls from pre-reg optometrists who are facing the pressures of starting their careers.
NAME:
Elin Daniel ROLE: Events coordinatorMany of these pre-regs have seen large parts of their education or training affected by the pandemic and restrictions. They might not have had the same level of exposure to patients in a normal practice setting. This additional pressure seems to be making things even more difficult for this cohort than in previous years.
The AOP is introducing an additional service to the PSL this year that will provide dedicated support to pre-regs.
The service runs on a referral basis so callers will still contact the PSL to speak with one of our volunteers. If the volunteer believes it might be helpful for the caller to be referred to the pre-reg service, they can offer for one of our pre-reg specialists, who are either pre-regs themselves or have recently qualified, to arrange an additional follow-up call.
The pre-reg specialists have received all of the same training as the PSL volunteers, and their calls will run in exactly the same confidential and non-judgemental way, but these will be true peers who understand the issues and pressures that pre-regs might be facing. On set days throughout the month, the pre-reg specialist will check in with referred callers to see how they are feeling, and if they would like to discuss the issues they are facing in more detail. As with the PSL, they will not be there to provide advice but to act as a listening service.


The confidential helpline for optical professionals saw an increase in calls in 2023
465
calls received by the helpline

125% in the number of calls compared to the previous year
26% of callers raised employment issues
14% of callers discussed issues with stress
14% of calls were regarding working conditions
10% of calls were linked to family and relationships.
It is really exciting to be launching this additional service. Over the past nine months we have been looking at what support we can offer to our existing PSL volunteers to ensure they had the best information. Our volunteers are fantastic listeners, but for some their prereg may have been a considerable time ago and have been in a different situation to the one the caller may be in. The pre-reg service is a new opportunity to expand the PSL, offering additional support for this group.
We have the most fantastic team of volunteers at the PSL. They are such an empathetic, positive, and caring group and volunteer because they really want to help people.
-
The confidential and free-phone Peer Support Line is available to members and non-members 24 hours a day, with volunteers on duty to return calls between 8am and 8pm. Call the Peer Support Line on 0800 870 8401.


Optometrists and dispensing opticians are eligible for the discount scheme. Carolyn Ruston, AOP policy director, said the news follows “constructive conversations” with the AOP.
www.aop.org.uk/bluelightcard
AOP external affairs officer, Freya Stenton, shared her top three sessions and the take home messages from the conference, hosted in London in February.
www.optometry.co.uk/blogs

The AOP’s employment law experts have produced new guidance for members covering changes in 2024. Read the guidance on the AOP website.
www.aop.org.uk/ topicalemploymentissues
Voting for elected and appointments for designated positions on Council close on 28 April, with results announced in May.
The AOP will host its AGM in June, followed by a Council meeting during which new AOP Councillors will formally take up their posts. Follow the coverage in OT
OT, in partnership with the AOP, will host a day of education dedicated to locum optometrists and delivered online. Find the AOP’s events programme at: www.aop.org.uk/events
“I’m
has moved forward”
Professor David Whitaker, recipient of the AOP’s Lifetime Achievement Award 2024, on research highlights, and how the profession has developed over four decades
In the late 1970s, with A-levels in maths, chemistry and physics, Professor David Whitaker’s then teacher suggested he become a chemical engineer. “But I wasn’t overly impressed with that,” he told OT. Whitaker has no regrets about his road not taken. Chemical engineering’s loss was optometry’s gain, and the native Bradfordian started his ophthalmic optics degree in Bradford in 1980.
His early career would see him complete a PhD at the University of Bradford, before he moved to Aston University, where he remained until the mid-1990s. After a handful of years at Aston University, he returned to his alma mater.
His early interests were in spatial vision and hyperacuity, which he describes as “a very fine ability of the eye and the brain to determine the spatial arrangement of the world around us.”
Whitaker also made an early foray into cataract research, explaining that, “in the 80s, cataract surgery was relatively underdeveloped in comparison to now.”
In more recent years, Whitaker has found an interest in multisensory perception – how the senses work together. “I’ve become interested in how visual auditory and tactile stimuli are put together, and how the brain makes sense of all the different pieces of information that come to it, and how it puts it together,” he said.

Professor David Whitaker received the AOP’s Lifetime Achievement Award at Excellence in eye care, supported by headline sponsor CooperVision. Scan the QR code to read more.
He explained that his career is no longer focused entirely on vision; it has expanded into other senses, including the human perception of time. “Historically, researching vision has been preoccupied with space: how we analyse the visual world around us, which is essentially spatial,” he said. “An under-developed area of research has been how humans perceive the temporal aspects of the world.”
Optometry four decades on OT is interested in hearing about how Whitaker believes optometry has changed over the course of his career. “It’s changed massively,” he said. “Optometry, back in the early 80s, was still junior, and rising out of what was more of a physics type of background. There weren’t many professors of optometry back then. In terms of its own academic reputation as a discipline, it probably hadn’t established itself. It was probably subservient to ophthalmology. But as the years have gone by, we’ve caught up with ophthalmology. ”
When asked about how he thinks optometry will change over the coming decade, Whitaker noted that, working in Cardiff, he is already seeing progress within the profession first-hand.
“I’m amazed at the way that the profession has moved forward in some areas of the country,” he said. “I’m seeing Wales and Scotland making great strides in terms of the treatment and the management of eye conditions, and links in pathways with ophthalmology.”
Whitaker believes that “the rest of the UK has got to catch up with the initiatives that have been firmly established and validated as being the proper way to go, particularly in an NHS that is stretched of resource. In the next decade, development simply has to continue.”
He added: “We need to get rid of the blockers. It has to be accepted that it is a no-brainer that optometry has to take more of a leading role in healthcare provision when it comes to the eyes.”

The world'sonly myopiamanagementcontact lens supportedby a 7-year clinicaltrial23 A

tUsingmeasuredandmodeleddata,pooledacrossages(8-17), MiSight®1 dayslowedmyopiaprogressionbyanaverageof approximately50%. =1=12monthspost-treatment,evidenceindicatesthat noaccumulatedmyopiacontrolbenefitswerelostfollowing3 or 6-yearsof MiSight®1 daywear (on average,for childrenagec 8-15 at start of wear). Instead,eye growth revertecto expected,age-normalrates.
1.Arumugam8etal.ModellingAgeEffectsofMyopiaProgressionfortheMiSight 1dayClinicalTrial./nvest.Ophthalmo/VisSci.2021 ;62(8): 233 3. 2. ChamberlainPetal. A3-year RandomizedClinicalTrialof MiSightLensesfor MyopiaControl.OptomVisSci.2019; 96(8): 556-567. 3. ChamberlainPet al. Long-term Effectof Dual-focusContact Lenseson MyopiaProgressionin Children:A 6-year MulticenterClinicalTrial.Optom VisSci.2022; 99(3): 204-212. 4. Chamberlain P et al. Myopia progressionon cessationof Dual-Focuscontact lenswear: MiSight 1 day 7-year findings.Optom VisSci.2021; 98(E-abstract): 210049. 5. ZadnikKet al. FactorsAssociatedwith RapidMyopia Progressionin School-agedChildren.Invest.Ophtha/mol.Vis.Sci.2004; 45(13): 2306. 6. HammondD,AnumugamB,et al. MyopiaControlTreatmentGainsareRetainedafter Terminationof Dual-focusContact LensWearwith no Evidenceof a ReboundEffect. OptomVisSci.2021; 98(E-abstract):215130.
© 2024 CooperVision.CooperVision®andMiSight®areregisteredtrademarksof TheCooperCompanies,Inc.anditssubsidiaries.
CVGY122291-1